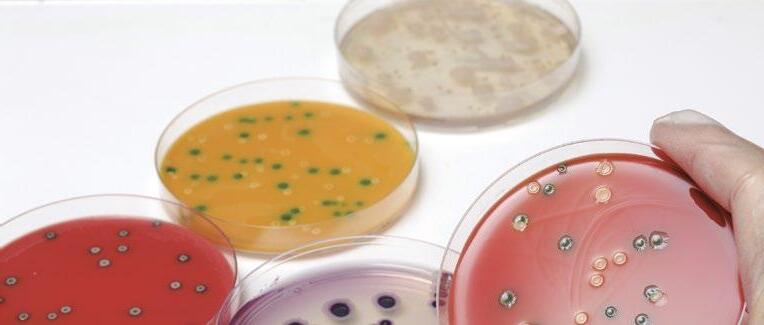
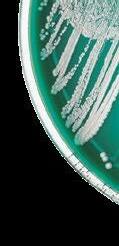
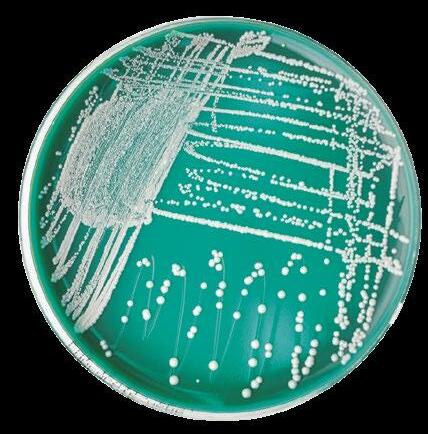
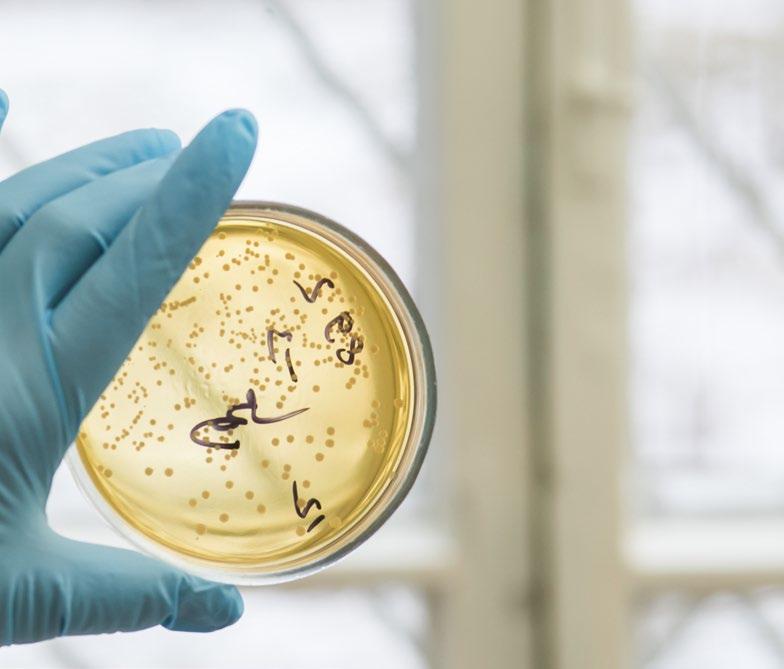
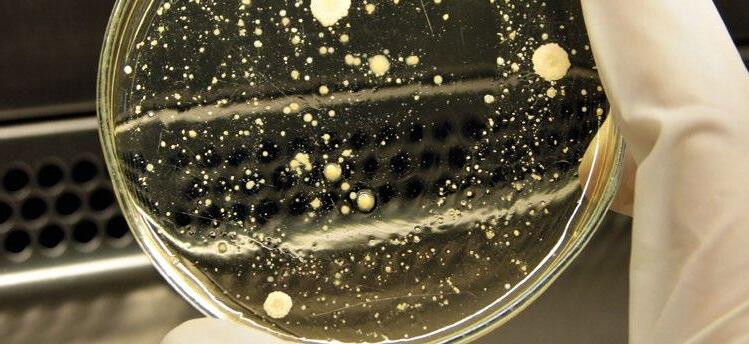

SUPLEMENTACIÓN PERINATAL
PRÁCTICA





![]()









Por su demostrada eficacia y seguridad, LIDERFEED es el ÚNICO GENUINO PROMOTOR DE CRECIMIENTO español aprobado por EFSA para la UE

(Register of Feed Additives pursuant to Regulation (EC) Nª 1831/2003 – Annex I.List of Additives https://ec.europa.eu/food/sites/food/files/safety/docs/ animal-feed_additives_eu-register_1831-03.pdf) Plaza García Lorca, 15 Bajos Tfno: (+34) 977 552316 43006 Tarragona (Spain) email: lidervet@lidervet.com
Ficha de materia prima:
Fuentes de fósforo 18

Investigadora IVIA
Microencapsulación de vitaminas
A y D3 : Una solución de ingeniería para la estabilidad de los aditivos para piensos
Adriana Barri, Yauheni Shastak, Wolf Pelletier, KP Chan
Equipo técnico de BASF
Uso de ácidos orgánicos, ácidos grasos y extractos de plantas en nutrición animal 36
57
Departamento técnico grupo PH-Albio
Alternativas proteicas para una nutrición sostenible: Explorando el potencial sinérgico de los concentrados proteicos no convencionales 22
Gestión del riesgo de coccidios mediante un fitobiótico en pienso o agua de bebida
Equipo técnico Idena
La oxidación, la amenaza silenciosa de la producción animal
J. Estévez, P. Martín & S. Carné
ITPSA. Departamento Técnico
El olivo, pilar de la dieta mediterránea, como estrategia para la mejora de la integridad intestinal
Equipo técnico Lucta
62
Departamento de MK Técnico de Andrés Pintaluba



Suplementación perinatal: una herramienta práctica para reducir el estrés oxidativo en porcino

Ana de las Heras Molina Universidad Complutense de Madrid
Potencial de los extractos fitogénicos en salud reproductiva: una mirada molecular con foco en la especie porcina



Henrietta Owusu1 , Esiosa F. Adewale2, Precious Adedayo Adesina3 , Tolulope Peter Saliu4 , Zhendong Zhu5 , Christian Xedzro 6 , Emmanuel Asiamah1 y Shahidul Islam1
1Universidad de Arkansas
2Universidad de Louisville
3NCATS
4Universidad de Kentucky
6Universidad de Hiroshima Alba Cerisuelo
5Universidad Agrícola de Qingdao
70
Efecto de Vitanox en la mejora de los parámetros productivos y estado sanitario del lechón en transición
Grandía J.1 , Sarasa R. 2 , Bruguera M. 3 y García, A. 3
1Agro-Test-Control
2Inneara Consultoría
3Agrifirm
76
Mejora del rendimiento de los lechones destetados: optimización de la Capacidad de Unión de Ácidos a pH 4 (ABC-4)
Dr. Yron Manaig
Responsable de I+D, Animine
82
Clostridium perfringens en porcino: impacto en las distintas fases de producción y estrategias clave de control
Equipo técnico Biocidas ZIX
89
Mejorar la eficiencia alimenticia mediante una herramienta única
Rafael Durán Giménez-Rico1 y Félix Calvo Falcón2
1Regional Technical Manager, IFF Danisco Animal Nutrition & Health
2Business Manager, IFF Danisco Animal Nutrition & Health
96
¿Es la arginina un nuevo aminoácido esencial en porcino?
Dr. Behnam Saremi
Head of technical marketing department, CJ Europe GmbH, Frankfurt am Main, Germany
102
Mejorando el estado sanitario y los resultados productivos con Zinc y Hierro en lechones destetados
Dr. Christof Rapp
Nutricionista porcino, Zinpro Corporation
108
Control biológico de micotoxinas en el alimento para aves

Dante Javier Bueno
Instituto Nacional de Tecnología Agropecuaria, EEA Concepción del Uruguay, Facultad de Ciencia y Tecnología, sede Basavilbaso, Universidad Autónoma de Entre Ríos
118
Uso combinado de enzimas en la nutrición de pollos de engorde: mecanismos, beneficios y sinergias
Elena Moreno
En representación del Equipo Técnico Nutrición Animal BASF
126
Efecto de la suplementación con Nuxasan sobre el desempeño y la salud intestinal en pollos desafiados con Eimeria spp.
Sol C 1 , Villalobos G 1 , Horta F 1 , López R 1,2 , Lee J3 y Kim W K 3
1Nuproxa Suiza, Vaud, Suiza
2Nuproxa México, Querétaro, México
3Departamento de Ciencias Avícolas, Universidad de Georgia, Athens, GA, EUA
128
Fósforo en la nutrición de rumiantes: eficiencia
productiva y marco regulador

Braulio De La Calle Campos
Director técnico en formulación de rumiantes
COREN agroindustrial

138
Una mano amiga para la ganadería lechera sostenible
Guillaume Desrousseaux
Ruminant market manager, Laboratoires Phodé

Fuente

Mejora de los parámetros productivos en aves y cerdos
No higroscópico
Reemplazo de colina sintética 60%


No altera la vida útil de las vitaminas
Fabricado exclusivamente en la Unión Europea

C/San Romualdo 12-14, Oficina 3º- 1
28039 Madrid (España)
info@liptosa com www liptosa com

Edulcorante natural para piensos a base de glicósidos de esteviol, extraídos de la planta stevia rebaudiana
TERMOESTABLE
HASTA LOS 198 OC
ALTAMENTE
HIDROSOLUBLE
ESTABLE EN UN RANGO AMPLIO DE PH
NO SE METABOLIZA EN EL ORGANISMO
NO FERMENTA
Aporta un dulzor de mayor intensidad, más estimulante, homogéneo y persistente.
Desencadena un efecto hedónico que aumenta la ingesta de alimento, estimula las secreciones digestivas, favorece la absorción de nutrientes y mejora los índices zootécnicos.
Producto estandarizado mediante rigurosos controles en todos los lotes.
Autorizado en la Unión Europea sin límites legales de dosificación, especies animales ni edades, según la EFSA.
Disponible tanto en versión líquida como sólida.
EDITOR
GRUPO DE COMUNICACIÓN AGRINEWS S.L.
La Fundación Española para el Desarrollo de la Nutrición Animal (FEDNA) se ha consolidado como un referente en la transferencia de conocimiento científico y técnico al sector de la alimentación animal.
Su misión es clara: promover el desarrollo sostenible y eficiente de la nutrición animal mediante la divulgación, la formación y la actualización constante de los profesionales del sector.
Uno de los pilares fundamentales de esta labor es el curso anual de FEDNA, un encuentro que reúne a técnicos, investigadores y empresas para debatir sobre los avances más relevantes. La organización del programa final del curso es un proceso meticuloso que refleja el compromiso del Patronato de la Fundación con la excelencia y la actualidad.
El primer paso consiste en la selección de los temas o bloques temáticos. Para ello, el Patronato analiza las tendencias más recientes en nutrición animal, desde innovaciones en formulación de piensos hasta estrategias para reducir el impacto ambiental. Además, se tienen en cuenta las propuestas de técnicos y profesionales del sector, garantizando que el contenido responda a las necesidades reales de la industria.
Una vez definidos los temas, se aborda la selección de los ponentes. Este proceso no se limita a la experiencia académica; se valora especialmente la trayectoria profesional y la capacidad de comunicación de cada candidato. El objetivo es ofrecer presentaciones rigurosas, pero también dinámicas y comprensibles, que faciliten a la audiencia la aplicación práctica del conocimiento.
Gracias a esta metodología y contando con la inestimable ayuda de las empresas del sector de alimentación animal, el curso anual de FEDNA alcanza este año su cuarenta aniversario y se ha convertido en un espacio imprescindible para quienes buscan anticiparse a los retos y oportunidades de la nutrición animal. Un foro internacional de reconocido prestigio donde ciencia y práctica se encuentran para impulsar el futuro del sector.

Gonzalo González
Mateos
Presidente de FEDNA
PUBLICIDAD
Laura Muñoz +34 629 422 552 laura@mediatarsis.com
Luis Carrasco +34 605 09 05 13 lc@agrinews.es
DIRECCIÓN TÉCNICA
José Ignacio Barragán (aves)
Guillermo Fondevila (porcinos)
Lourdes Cámara (porcinos)
Fernando Bacha (rumiantes)
COORDINACIÓN TÉCNICA
Facundo Apecetche
REDACCIÓN
Amanda Abalo
Daniela Morales
COLABORADORES
Juan Acedo-Rico (Consultor)
Joaquim Brufau (IRTA)
Lorena Castillejos (SNiBA)
Carlos De Blas (UPM)
Gonzalo Glez. Mateos (UPM)
Xavier Mora (Consultor)
Edgar O. Oviedo-Rondón
Alba Cerisuelo (CITA-IVIA)
Carlos Fernández (UPV)
ADMINISTRACIÓN
Mercè Soler
Tel: +34 93 115 44 15 info@grupoagrinews.com www.nutrinews.com
Precio de suscripción anual: España 30 €
Extranjero 90 €
GRATUITA PARA FABRICANTES DE PIENSO, EMPRESAS DE CORRECTORES Y NUTRÓLOGOS
Depósito Legal Nutrinews B-17990-2015
Impreso - ISSN 2696-8053
Digital - ISSN 2696-8045
EDICIÓN TRIMESTRAL
Alba Cerisuelo IVIA

Los minerales son nutrientes esenciales cuyas deficiencias pueden tener efectos negativos sobre la salud, rendimiento productivo y la reproducción de los animales, entre otros. El fósforo (P) es el segundo mineral más abundante en el cuerpo de los animales, después del calcio.
Entre las funciones del P destaca la de conferir solidez y firmeza a los huesos, cáscara de huevo o las conchas de moluscos, entre otros, aunque también tiene otras funciones no estructurales como son su participación en el metabolismo energético y actividad enzimática, formar parte de las membranas celulares (fosfolípidos) y del ARN y ADN.
Las fuentes de P utilizadas en alimentación animal pueden ser de origen vegetal, animal o mineral.
Los ingredientes vegetales tienen una concentración de P generalmente baja (entre 0,09% - 1,09%) y, además, en estos, el P está en forma de fitatos, que son formas iónicas del ácido fítico ligados a carbohidratos o proteínas en sus estructuras más complejas.

Las fuentes de P de origen animal, como son las proteínas animales procesadas (PAPs) o las harinas de pescado o huesos, a pesar de contener un mayor porcentaje de P (entre 50-70%, aproximadamente) y presentar mayores digestibilidades de este mineral que las fuentes vegetales, son menos utilizadas por sus actuales restricciones sanitarias y económicas, y por su elevada variabilidad.
El P unido a fitatos no puede ser utilizado por los animales monogástricos, por lo que el valor biológico del P vegetal en estas especies depende del contenido en P fítico y de la actividad fitasa (enzima capaz de hidrolizar el fitato y liberar P inorgánico) endógena de cada materia prima.
En el caso de animales rumiantes, el escenario es algo diferente ya que se asume que la presencia de fitasas y fosfatasas microbianas en el rumen les permite utilizar gran parte del P fítico presente en los vegetales (Humer and Zebeli, 2015).
Por otro lado, es importante tener en cuenta que las fitasas endógenas son termosensibles por lo que las materias primas que han sido sometidas a tratamientos térmicos pueden presentar menor actividad fitásica endógena.
La biodisponibilidad del P de origen vegetal puede mejorarse sustancialmente con el empleo de fitasas exógenas en piensos y raciones, para las cuales existe una amplia oferta en la actualidad.
Las fuentes de origen mineral (fosfatos inorgánicos, principalmente) son, hoy en día, las más utilizadas en piensos, ya que aportan mayor cantidad de P, son más constantes en su composición y su digestibilidad puede ser elevada. En ellas se va a basar esta ficha.
En la Tabla 1 se muestran algunas de las materias primas que son consideradas fuentes de P mineral y clasificadas como “Minerales y sus productos derivados”, que se recogen en el Catálogo de materias primas (Reglamento UE 68/2013).

Número Denominación
11.3.1.
Fosfato dicálcico [ortofosfato de calcio e hidrógeno]
11.3.2
11.3.3
11.3.4
11.3.5
11.3.6
Fosfato monodicálcico
Fosfato monocálcico [diortofosfato de calcio y tetrahidrógeno]
Fosfato tricálcico [ortofosfato de tricalcio]
Fosfato cálcicomagnésico [fosfato de calcio y magnesio]
Fosfato desfluorado
Descripción
Fosfato de calcio monohidrógeno obtenido a partir de huesos o de sustancias inorgánicas (CaHPO 4 × nH2O, n=0 o 2). Ca/P > 1,2 Puede contener hasta un 3% de cloruro, expresado en NaCl.
Producto compuesto de fosfato dicálcico y monocálcico [CaHPO 4 × Ca(H2PO 4) 2 × nH2O, n=0 o 1] 0,8<Ca/P<1,3
Bis-dihidrogenofosfato de calcio [Ca(H2PO 4) 2 × nH2O, n=0 o 1] Ca/P<0,9
Fosfato de tricalcio procedente de huesos o de sustancias inorgánicas [Ca 3 (PO 4) 2 × H2O) o hidroxiapatita (Ca5(PO 4)3 OH] Ca/ P>1,3
Fosfato cálcico-magnésico [Ca3Mg3(PO 4)4]
Producto obtenido a partir de sustancias inorgánicas, calcinado y sometido a un tratamiento térmico posterior.
Calcio, P total, P insoluble en un 2% de ácido cítrico, cuando sea >10%, ceniza insoluble en HCl, cuando sea >5%.
P total, Calcio, P insoluble en un 2% de ácido cítrico, cuando sea >10%
P total, Calcio, P insoluble en un 2% de ácido cítrico, cuando sea >10%
Calcio, P total, P insoluble en un 2% de ácido cítrico, cuando sea >10% Ceniza insoluble en HCl, cuando sea >5%.
Calcio, magnesio, P total, P insoluble en un 2% de ácido cítrico, cuando sea >10%
P total, calcio, sodio, P insoluble en un 2% de ácido cítrico, cuando sea >10%, ceniza insoluble en HCl, cuando sea >5%.
Tabla 1. Fuentes de fósforo (P) más relevantes autorizadas para alimentación animal según el Catálogo de Materias Primas (Reglamento UE 68/2013).
En general, el control de calidad de las principales fuentes de P incluye la determinación del P total, P insoluble y la concentración de otros minerales como el calcio o el sodio.
Procesodeobtención
La mayoría de los fosfatos inorgánicos derivan de fosfatos de rocas naturales, presentes principalmente en África, el norte de Europa, Asia, Oriente Medio y Estados Unidos.
Sin embargo, estos no son aptos para su uso directo en la alimentación animal y precisan un tratamiento previo. En primer lugar, para poder utilizarlos en alimentación animal, deben eliminarse materiales indeseables circundantes, como arena y arcilla. Este proceso puede variar considerablemente de un yacimiento a otro, debido a las diferencias en composición de la roca.
Posteriormente, el fosfato mineral se suele secar en un secador rotatorio (o de otro tipo). El procesado en un horno rotatorio puede ser también necesario para eliminar otras impurezas que puede tener el fosfato tales como flúor, cadmio y arsénico, que, si no se eliminan en el proceso de producción, los hacen inadecuados para ser usados en nutrición animal.

Mayor resistencia a los desafíos
Rendimiento optimizado
Asociación única de extractos de macroalgas biológicamente activos (MSP®)






PROPIEDADES BRONCODILATADORAS
MEJORA LA INMUNIDAD LOCAL
ACTIVIDAD MUCOLÍTICA Y EXPECTORANTE
PROTEGE DEL ESTRÉS OXIDATIVO
REDUCCIÓN DE LA RESPUESTA INFLAMATORIA

Una vez seco el mineral de fosfato, este se hace reaccionar con ácido sulfúrico (aunque también puede usarse ácido clorhídrico) para producir ácido fosfórico (Figura 1). Los usos más comunes del ácido fosfórico son la producción de fertilizantes fosfatados e ingredientes para alimentación animal.

Roca con fosfatos
Reacción con ácido sulfúrico
1. Esquema del proceso de obtención de ácido fosfórico (Lee et al., 2023).
Los fosfatos más utilizados en alimentación animal son el fosfato bicálcico (DCP) y el fosfato monocálcico (MCP) (Petersen et al., 2011). El fosfato tricálcico, el fosfato monosódico y el fosfato de magnesio son también utilizados en piensos, aunque no tan frecuentemente.
2. Producción de fosfato bicálcico (DCP) y monocálcico (MCP) a partir del ácido fosfórico (Lee et al., 2023).
El DCP y el MCP se obtienen mediante la reacción del ácido fosfórico con carbonato de calcio y la granulación del material resultante (Figura 2).
La producción de DCP y MCP es un proceso continuo en el que la cantidad final de P en el producto se controla a través de la reacción entre el ácido fosfórico y el carbonato de calcio.
Generalmente, para la producción de DCP, la reacción entre el ácido fosfórico y el carbonato de calcio se detiene al 18,5% de P, pero la reacción continúa hasta que el producto contiene 21,0 % de P si se produce MCP.
Por lo tanto, los productos finales suelen tener una concentración relativamente constante de P, aunque a menudo se observan variaciones en las concentraciones de Ca.
En la Tabla 2 se muestra la composición (en materia seca, MS) de diferentes DCP y MCP disponibles para alimentación animal según diferentes fuentes (FEDNA, CVB e INRAE).
El contenido en P en todas ellas se encuentra en torno al 19-23% en materia seca y su contenido en calcio se encuentra entre un 17 y un 28%.

Como es lógico, el MCP contiene un menor contenido en calcio y mayor en P que el DCP. Además, la digestibilidad/aprovechamiento del P es mayor en el MCP que en el DCP, al menos para animales monogástricos como el porcino y las aves. En rumiantes esta diferencia parece ser menor.
Además, estos ingredientes pueden contener otros minerales, como:
Manganeso
Zinc
Magnesio
Potasio
Azufre
Cobre
Hierro
Este dato es importante tenerlo en cuenta de cara a la formulación de piensos con estos ingredientes.
Otras fuentes de P como el fosfato monobicálcico, tricálcico, el fosfato monosódico y el fosfato de magnesio también están disponibles para alimentación animal.
Estos ingredientes tienen, generalmente, una menor concentración de P que los anteriores, pero aportan mayores cantidades de otros minerales como calcio o magnesio.


Actualización 2025



“Tabla de Fitogénicos” PON EN GOOGLE



1 http://www.fundacionfedna.org/ingrediente; valores expresados en materia seca
2 https://www.cvbdiervoeding.nl/pagina/10021/home.aspx. CVB Feed Table 2023. Chemical composition and nutritional values of feedstuffs; valores expresados en materia seca
3 https://feedtables.com/content/table-dry-matter; valores expresados en materia seca
4 Debido al elevado contenido en P de estos ingredientes la digestibilidad aparente y estandarizada son muy similares
Tabla 2. Composición química (en materia seca) de distintas fuentes de fósforo en alimentación animal.
Las fuentes inorgánicas son las más utilizadas como fuente de P en los piensos. Sin embargo, diferentes estudios demuestran que la digestibilidad del P en las diferentes fuentes disponibles puede variar considerablemente (Figura 3).
Fosfato
Fosfato
Fosfato monosódico
Fosfato de magnesio
Figura 3. Coeficiente de digestibilidad total estandarizada del fósforo (STTD-P) de diferentes fuentes minerales en porcino (Petersen and Stein (2006); NRC (2012); Baker et al (2013); Kwon and Kim (2017); and Lopez (2020)).
Según estos resultados, los ingredientes que presentan una mejor digestibilidad de P en porcino son MCP y el fosfato monosódico. Algunos estudios apuntan a que la presencia de calcio reduce la digestibilidad y absorción del P debido a que la interacción entre estos dos minerales presenta complejos Ca-P indigestibles que precipitan en el tracto intestinal de los animales (Selle et al., 2009).
Esto explicaría el hecho de que las fuentes con más calcio presenten menores digestibilidades del P (Figura 3).
Según Xiuhua et al. (2016), en el caso de las aves, los ingredientes que presentan mayores valores de retención de P son también el fosfato monosódico (2%) y el MCP, siendo los valores para el DCP muy similares a los de MCP. Al igual que en porcino, altos niveles de calcio pueden afectar negativamente a la retención de P.

En rumiantes, es necesario tener en cuenta que no sólo el animal, sino su microbiota, tienen unas necesidades importantes de P. En este sentido, cuando la concentración de P es inferior a 50-80 mg/l, es probable que la actividad de los microorganismos del rumen y ciego se minimice debido a una reducción en la degradación de la celulosa y la hemicelulosa.
También en rumiantes, niveles excesivos de calcio parecen afectar negativamente a la absorción de P, aunque los rumiantes son capaces de tolerar un mayor rango de ratios Ca:P que los animales monogástricos (Qureshi and Deeba, 2019).
En animales rumiantes, la diferencia en el aprovechamiento de las diferentes fuentes no es tan elevada como en monogástricos, ya que disponen de otros mecanismos para degradar el P.


Aparte de la fuente de P y el nivel de Ca, la disponibilidad de P en los fosfatos también depende de su forma química, el tamaño de partícula o el tratamiento térmico que reciban ya que, si el tratamiento térmico es agresivo, pueden formarse complejos pyro- y meta- que reducen de manera drástica la biodisponibilidad del P en fuentes inorgánicas.
Al margen de las fuentes convencionales de P que se han tratado en esta ficha, es relevante señalar que nuevas investigaciones apuntan a que la obtención de P reciclado procedente de lodos de depuradora, entre otros residuos, para su utilización en alimentación animal podría ser viable y generar nuevas fuentes de fosfato más sostenible.
Las fuentes de P inorgánico son las más utilizadas para aportar este mineral en los piensos. Estas contienen entre un 15 % y un 26 % de P, y los valores de la digestibilidad total estandarizada del P varían según el tipo de fosfato.
Disponer de datos de biodisponibilidad de este mineral en los diferentes ingredientes es crucial para poder formular dietas con mayor precisión y reducir la excreción de P y sus efectos sobre el medioambiente.
Para ello se requiere una estandarización de los procesos de determinación de la biodisponibilidad de este mineral a nivel global. Además, teniendo en cuenta que el P mineral es finito, una formulación más precisa junto con la búsqueda de fuentes alternativas de P son necesarias para asegurar la disponibilidad de P en un futuro.

Referencias disponibles en la versión web del artículo en nutrinewes.com
Fuentes de fósforo DESCÁRGALO EN PDF
INTRODUCCIÓN
Adriana Barri, Yauheni Shastak, Wolf Pelletier, KP Chan
Equipo técnico de BASF
VÍAS DE DEGRADACIÓN
Este breve artículo examina las vulnerabilidades de las vitaminas A y D3 y la justificación de su formulación. Además, detalla la tecnología de microencapsulación empleada en Lutavit® A/D₃ 1000/200 NXT, demostrando su eficacia para mejorar la estabilidad y biodisponibilidad de la vitamina en matrices de piensos.
La vitamina A (retinol) y la vitamina D₃ (colecalciferol) son micronutrientes liposolubles esenciales indispensables en la nutrición animal.
La vitamina A contribuye a la visión, la integridad epitelial, la función inmunitaria y la reproducción, mientras que la vitamina D₃ regula la homeostasis calcio-fósforo a través de su metabolito activo, el calcitriol.
Las deficiencias se manifiestan como retraso del crecimiento, problemas de visión, raquitismo y osteomalacia1,2. La inestabilidad química de ambas vitaminas, sometidas a factores de estrés ambiental como el calor, la luz y el oxígeno, supone un reto importante en la fabricación y el almacenamiento de piensos, por lo que se necesitan estrategias avanzadas para su estabilización.
El retinol consta de un anillo de β-ionona y una cadena lateral de polieno con dobles enlaces conjugados, lo que lo hace susceptible a la oxidación y la isomerización. El colecalciferol, un secoesteroide, presenta un sistema de anillos de esteroles con dobles enlaces exocíclicos y un grupo hidroxilo, igualmente vulnerable a la escisión oxidativa (Figura 1).
FACTORES DE ESTRÉS
AMBIENTAL Y SU IMPACTO1,2


Ambas moléculas son lipofílicas y se degradan por mecanismos fotolíticos y oxidativos, especialmente en condiciones ambientales durante la producción de premezclas, el peletizado y el almacenamiento. Su reactividad compartida y su proximidad en mezclas desprotegidas pueden exacerbar la degradación mutua a través de intermediarios reactivos como el oxígeno singlete y los radicales peroxilo1,2.
La luz: La radiación UV induce la isomerización del retinol y la fotólisis del colecalciferol, dando lugar a formas biológicamente inactivas.
Calor: Las temperaturas elevadas aceleran la degradación mediante un aumento de la cinética molecular.
Oxígeno: Las especies reactivas del oxígeno (ROS) alteran los dobles enlaces conjugados de las vitaminas, formando productos degradados inactivos.
Variabilidad del pH: Ambas vitaminas son estables en condiciones neutras a ligeramente ácidas, pero se degradan en entornos de pH extremo debido a la sensibilidad al hidroxilo y al doble enlace.
PROCESO DE MICROENCAPSULACIÓN Y CONOCIMIENTOS MECANÍSTICOS
La tecnología de microencapsulación de BASF consiste en emulsionar acetato de retinilo y colecalciferol en aceite de girasol con butilhidroxitolueno (BHT) como antioxidante. Esta emulsión se atomiza en una cámara calentada, formando partículas esféricas (~300 µm) que se recubren con sílice fría y se secan en un lecho fluidizado.
La matriz de encapsulación, compuesta de azúcar y proteínas, actúa como barrera contra la humedad, el oxígeno y la luz, preservando la bioactividad de las vitaminas. El producto final es Lutavit® A/D₃ 1000/200 NXT, un polvo en perlas con un fino tamaño de partícula.
VALIDACIÓN DE LA ESTABILIDAD Y MÉTRICAS DE RENDIMIENTO
En las pruebas de estabilidad en condiciones de almacenamiento acelerado (40°C, 75% HR), Lutavit® A/D₃ 1000/200 NXT retuvo el ~85% de la actividad inicial de la vitamina A y no mostró una degradación significativa de la vitamina D₃ durante seis meses (Figura 2). Estos resultados confirman la robustez del sistema de encapsulación. El empaque contribuye además a la estabilidad al limitar la exposición a factores de estrés ambiental.
Recuperación de las vitaminas a lo largo de 6 meses en 40°C/75% HR
Vitamina A
Vitamina D3
Figura 2. Estabilidad de las vitaminas A y D₃ en Lutavit® A/D₃ 1000/200 NXT a 40 °C/75% HR durante 6 meses (media ± DE, n=4). Muestras de 4 lotes piloto almacenadas en envases originales sellados. Estudio 23H00016 de BASF.
ESTRATEGIA DE FORMULACIÓN Y JUSTIFICACIÓN TECNOLÓGICA
La formulación de las vitaminas A y D₃ ofrece ventajas sinérgicas:
Protección unificada: Las vías de degradación compartidas permiten la estabilización simultánea mediante microencapsulación.
Eficiencia de dosificación: Una relación fija de 5:1 A:D₃ garantiza una distribución uniforme en todos los tipos de piensos.
Tecnología de formulación validada: Lutavit® A/D₃ 1000/200 NXT se basa en la probada tecnología de microencapsulación de BASF utilizada en Lutavit® A 1000 NXT.
Ventajas de aplicación: Mejor fluidez, menos polvo y menor número de ingredientes necesarios, lo cual agiliza los pasos de formulación y acelera los ciclos de producción para diversas matrices de piensos.
Almacenamiento eficiente: La combinación de vitaminas A y D₃ en una formulación reduce el espacio de almacenamiento y la manipulación, ideal para instalaciones con capacidad limitada de clima controlado.
CONCLUSIÓN
La microencapsulación de vitaminas A y D₃ representa una solución de ingeniería científica a los retos de inestabilidad de los micronutrientes liposolubles en los piensos. Lutavit® A/ D₃ 1000/200 NXT de BASF es un ejemplo de cómo la tecnología de formulación puede salvaguardar la integridad de las vitaminas, garantizando una administración uniforme y favoreciendo el bienestar y la productividad de los animales.
Referencias
1 McDowell (ed.), Capítulo 2: Vitamina A, En: Vitamins in Animal and Human Nutrition, 2000.
2 Wu G (ed.), Capítulo 9: Nutrición y metabolismo de las vitaminas, En: Principles of Animal Nutrition, 2018.

Microencapsulación de vitaminas A y D₃: Una solución de ingeniería para la estabilidad de los aditivos para piensos DESCÁRGALO EN PDF
Hace treinta años, en 1995, unos cuantos hombres y mujeres decidieron creer en una idea un poco loca: hacer nutrición animal de forma diferente.
Soñaban con una empresa independiente, impulsada por la innovación y cercana al terreno. Así nació IDENA, con una misión clara: “Alimentar bien a los animales para la armonía de la naturaleza y el hombre”.


Desde aquel día, las páginas se han sucedido como en un gran libro colectivo. Desde la primera fábrica en Pontchâteau hasta los primeros pasos en la escena internacional, desde los premios a la innovación hasta la creación hace casi 15 años de una filial en España, la nueva filial en Rumanía y otros proyectos en desarrollo, cada etapa ha estado marcada por un deseo compartido: inventar, atreverse, avanzar juntos.
En la actualidad, IDENA emplea a más de cien personas y tiene un alcance mundial, pero nunca ha perdido la esencia de su identidad: independencia, espíritu pionero y la convicción de que el futuro se construye trabajando en equipo.
LA COCCIDIOSIS SIGUE SIENDO UN GRAVE PROBLEMA: ¿CUÁL ES EL INTERÉS ACTUALMENTE DE UNA ALTERNATIVA?
La coccidiosis es la enfermedad parasitaria más común y económicamente importante en animales de producción, causada por protozoos intracelulares del género Eimeria e Isospora
La coccidiosis es una enfermedad muy contagiosa que provoca graves problemas intestinales.
La enfermedad se caracteriza por malabsorción, disminución del rendimiento con un aumento de la conversión alimenticia, y menor bienestar animal
Como resultado, sigue causando pérdidas económicas sustanciales en todo el mundo.

A nivel mundial, la quimioprofilaxis se utiliza para prevenir la coccidiosis mediante la inclusión de diferentes aditivos coccidiostáticos en su alimentación, que inhiben el crecimiento y la replicación de Eimeria spp. e Isospora spp.
Los aditivos coccidiostáticos están regulados por la Directiva CE nº 1831/2003 y actualmente once de ellos están aprobados para su uso en alimentación animal (Afssa, 2007; Unión Europea, 2022).
El uso generalizado de estos aditivos coccidiostáticos ha aumentado el riesgo de resistencia. Como resultado, algunos pueden perder eficacia con el tiempo, a medida que los coccidios desarrollan una resistencia cruzada parcial a ellos.
Las estrategias tradicionales de control se han basado principalmente en el uso de fármacos anticoccidianos. De hecho, el uso de profilaxis para controlar la coccidiosis ha sido una práctica habitual desde mediados del siglo pasado.


En un estudio realizado en colaboración, IDENA y el INRAE AIM (Apicomplexa e Inmunidad de Mucosa) demostraron in vitro los efectos de determinadas sustancias aromáticas en diferentes fases del desarrollo de las coccidias (esporulación, invasión y desarrollo en la célula intestinal (A. Mahieu, Gnahoui-David & al, WPC2022).
Además, otros trabajos de Investigación y Desarrollo realizados por IDENA en colaboración con la Universidad de Lille 2 (Derecho y Salud) han demostrado la eficacia in vitro de determinadas sustancias aromáticas sobre bacterias patógenas, entre ellas C. perfringens (Dubreuil, 2015).
La actividad contra el ooquiste se determinó por la capacidad de los ingredientes activos para limitar la esporulación del ooquiste de E. tenella tras un periodo de incubación de 72h a 26°C.
A continuación generamos cepas transgénicas de Eimeria para monitorizar fácilmente el efecto anticoccidial de los ingredientes activos in vitro, en las fases de invasión o desarrollo en células epiteliales.
Se midió el Índice de Selectividad (IS), que es la relación: eficacia/toxicidad.



Se generaron dos cepas recombinantes de E. tenella para analizar la eficacia de 150 compuestos de la biblioteca IDENA frente a varias fases del ciclo biológico del parásito. Parte de los resultados se presentan en la figura
Esporulación: 6 compuestos (por ejemplo, A y D) restringieron la esporulación de ooquistes de E. tenella en más del 90%.
Invasión: 3 compuestos (por ejemplo, Q y BB) limitaron la invasión al menos en un 50% con IS >12.
Desarrollo asexual: 15 compuestos inhibieron el desarrollo del parásito en células epiteliales con una eficacia del 50% al 100% y un IS que podía ser superior a 100 (por ejemplo, C, D, T, 19).
A C D Q T AF BB 19 Índice de selectividad IS %Máxima e cacia INVASIÓN
%Máxima e cacia DESARROLLO
%Máxima e cacia ESPORULACIÓN

IDENA ha desarrollado varias soluciones fitobióticas para el manejo de riesgos asociados a la presencia de coccidia.
Las soluciones FORCIX:
Tenemos versión en polvo y versión líquida para utilizar en piensos para aves de corral y también una versión específica para rumiantes.
Es una gama de productos comerciales a base de sustancias aromáticas y extractos de plantas, que han demostrado su actividad sobre el ciclo de Eimeria y/o sobre bacterias patógenas, incluida C. perfringens, en estudios in vitro.
Tenemos también una solución líquida pensada para su uso en lechones, PIGGY CLEAN , diseñada y fabricada por IDENA con su tecnología ECHV para favorecer el rendimiento de los lechones durante las fases críticas de la cría relacionadas principalmente con la presencia de coccidios.
PIGGY CLEAN: Prevención de riesgos de disbiosis digestiva en lechones en la maternidad
La coccidiosis es un trastorno digestivo frecuente en los lechones en paridera (entre el 40% y el 70% de prevalencia según estudios realizados desde 2005).
Se manifiesta con mayor frecuencia entre los 8 y los 15 días de edad por diarrea, reducción del rendimiento del crecimiento y un mayor riesgo de mortalidad.

En los sistemas de producción modernos, la microbiota intestinal del lechón depende en gran medida del contacto con las heces, la piel y las membranas mucosas de la cerda desde el nacimiento.
Así, el ambiente microbiano materno es un factor determinante en el estado de salud de los recién nacidos. Tradicionalmente, la prevención se ha basado en la administración de antiprotozoos directamente a los lechones a los pocos días del parto.
Sin embargo, la búsqueda de soluciones naturales alternativas se está intensificando debido a las expectativas de la sociedad con respecto a la reducción del uso de anticoccidios y el manejo racional de los medicamentos.
El trabajo in vitro ya ha demostrado que ciertos aceites esenciales pueden interrumpir el ciclo de desarrollo de los coccidios.
Sobre esta base, se planteó la hipótesis de que una ingesta específica de aceites esenciales a la cerda, antes del parto, podría influir positivamente en la microbiota fecal materna y limitar el riesgo de diarrea en los lechones.

El estudio se realizó en una granja comercial donde la coccidiosis era endémica, con casos habituales entre los 8 y 15 días de edad. Un total de 106 cerdas (paridad 1 a 7) fueron asignadas aleatoriamente a dos grupos:
Grupo control (T1): cerdas alimentadas según la ración estándar. Sus lechones recibieron el tratamiento farmacológico el día 3 después del parto.

Media: T1=237 / T2=253
Grupo tratamiento (T2 ): cerdas que reciben una dosis única de la mezcla de aceites esenciales PIGGY CLEAN (Idena, Francia), ON-TOP en la ración diaria 5 a 6 días antes del parto. No se administró tratamiento farmacológico a los lechones en este grupo.
Los parámetros reproductivos (número total de nacimientos, nacidos vivos, mortalidad) no difirieron entre los grupos, lo que demuestra que el tratamiento materno no afecta la prolificidad ni la supervivencia neonatal. Por otro lado, se observaron diferencias significativas en el crecimiento y la salud digestiva de los lechones:
Ganancia media diaria (GMD): Los lechones del grupo “tratamiento” mostraron una media de +16 g/día de mayor crecimiento en comparación con el grupo “control” (P = 0,005).
Puntuación fecal en el día 8 : se observó una tendencia hacia una mejor consistencia fecal en el grupo de tratamiento (–0,45 puntos en la escala de 1 a 4; P = 0,093).
Estos resultados indican que la administración de PIGGY CLEAN a las cerdas antes del parto redujo el riesgo de diarrea en los lechones, incluso en ausencia de terapia anticoccidiana directa
Media: T1=1,76 / T2=1,31
Figura 2. Efecto del tratamiento sobre la GMD y la Puntuación fecal.
El interés práctico de esta estrategia es doble.
Por un lado, permite reducir o eliminar el uso de medicamentos en lechones, cumpliendo con los requisitos de limitación de anticoccidios.
Por otro lado, mejora el rendimiento del crecimiento, un factor clave para la rentabilidad de las granjas.
Este enfoque materno, basado en extractos naturales, ofrece una alternativa creíble a los anticoccidiales sintéticos utilizados tradicionalmente en la cría de cerdos.
FORCIX FEED: Ensayo sobre terneros en estación experimental
Se hizo un ensayo sobre terneros en colaboración con la Facultad de Medicina Veterinaria de Mongolia Interior, en China.

Se utilizaron dos lotes de terneros (Prim’Holstein), desde el nacimiento hasta los 4 meses de edad.
T1
T2
No infectado y no suplementado = Control negativo - - No
Infectados y No tratados = control positivo - -
T3
Tabla 1. Efecto de la adición de Forcix Feed en la GMD y la ocurrencia de diarreas.
En este ensayo la adición de FORCIX FEED ha permitido mejorar significativamente el ambiente intestinal de los terneros y reducir la tasa de diarrea en casi un 50%,
lo que no solo mejora en gran medida su salud, sino también reduce el costo de la medicación y la carga de trabajo y aumenta la GMD.
FORCIX PY: Ensayo en pollos con desafío Eimeria comparado con toltrazuril
En 2017, un ensayo realizado en una estación experimental de Bélgica demostró que FORCIX PY LÍQUIDO, la solución fitobiótica de IDENA para el manejo de riesgos de coccidias en aves de corral, suministrado en agua de bebida, era igualmente eficaz contra un desafío coccidial en comparación con el uso de toltrazuril.
T4
Infectados y tratados D17-21
Infectados y tratados D17-18
FORCIX PY LIQ: 1ml/ L de agua
Toltrazuril (25ppm): 1ml BAYCOX /L agua
Sí, el día 16 (E. acervulina, tenella, maxima y mitis)
Cantidad de ooquistes / ml de inóculo. Inóculo= 0,5 ml/ pollo - 10% de mortalidad
Cómo utilizar la solución fitobiótica de IDENA para el manejo de coccidia en el agua de bebida en aves de corral
La coccidiosis se previene en las aves de corral añadiendo coccidiostáticos a los piensos o mediante vacunación.
Se han observado resistencias y patologías subclínicas, con aparición de síntomas en lotes (plumas erizadas, diarrea, etc.).
A menudo se aplican medidas metafilácticas mediante aditivos en el agua de bebida:
Toltrazuril: 2 días de tratamiento (tener en cuenta el período de espera de 16 días antes del sacrificio)
Amprolium: 5 días de tratamiento y puede ser rechazado por las DOP “sin antibióticos”.
El uso de nuestra solución líquida puede contribuir al rendimiento de los lotes por distribución durante los períodos de riesgo ligados a la presencia de coccidios, particularmente entre los 18 y 25 días de edad en pollos tipo ROSS/COBB.
Las soluciones de IDENA para la gestión del riesgo de coccidia a través del pienso o del agua de bebida son cada vez más utilizadas para apoyar a las explotaciones y limitar los riesgos asociados a los coccidios y clostridios.
De este modo, nuestras soluciones contribuyen a alcanzar los objetivos de rendimiento de los distintos tipos de producción.

en pienso + FORCIX PY LIQ agua de bebida
Inicio Crecimiento Final Retirada
Anticoccidianos en los alimentos 29-34d
D+0 10 20
FORCIX PY LIQ®
0,9 L /1000 L de agua potable durante 5 días 30 42
La utilización de FORCIX PY LIQ como complemento de un programa anticoccidiano puede limitar los efectos negativos de la Eimeria resistente.
Más allá de la prevención de los riesgos asociados a la presencia de coccidia, las soluciones de IDENA ilustran el interés de las soluciones fitogénicas en una industria que busca innovaciones que respeten la salud animal, el medio ambiente y las expectativas de la sociedad.

Gestión del riesgo de coccidios mediante un fitobiótico en pienso o agua de bebida DESCÁRGALO EN PDF

Ayuda a preservar la sensibilidad bacteriana
Favorece las transformaciones (GMD, IC)
Previene el riesgo asociado a la presencia de coccidia


J. Estévez, P. Martín & S. Carné ITPSA. Departamento Técnico y de Innovación. jestevez@itpsa.com

En nutrición animal, la oxidación del pienso sigue siendo un desafío, en muchos casos subestimado e incluso ignorado. Algunos fabricantes aplican controles eficaces, pero otros, pese a su rigor en la formulación, no la consideran un factor crítico.
Esta omisión reduce el valor nutricional, afecta salud y rendimiento, y genera pérdidas económicas.


La oxidación del pienso es un proceso químico autocatalítico asociado con la reacción del oxígeno con moléculas susceptibles, como los ácidos grasos insaturados. Por tanto, uno de los efectos directos de la oxidación del pienso es la reducción de la calidad nutricional y de los valores energéticos de la dieta (Shurson et al., 2015).
Racanicci et al. (2004) comprobaron que la energía metabolizable aparente corregida por nitrógeno (AMEn) en grasa de ave disminuye hasta un 17% tras su oxidación.
De forma similar, Ehr et al. (2015) reportaron que la inclusión de aceite de maíz peroxidado redujo la AMEn del pienso en pollos de 3.490 kcal/kg con aceite fresco a 3.344 kcal/kg con aceite oxidado (fig. 1), lo que representa pérdidas de hasta el 4,2%.



Figura 1. Adaptada de Ehr et al. (2015), AMEn de pollos (kcal/kg) alimentados con dietas con 10 % de aceite de maíz fresco (UO), calentado lentamente a 95 °C/72 h (SO) o calentado rápidamente a 185 °C/12 h (RO). Letras distintas indican diferencias significativas (P ≤ 0,05); n = 10.
En aves, se han descrito reducciones en la digestibilidad de lípidos de hasta un 11% con aceites oxidados (Yaseen et al., 2021). Este efecto es relevante; la energía es uno de los componentes más costosos del pienso y factor crítico en su coste, considerando además que el pienso representa más del 60% de los costes productivos en monogástricos.
Además, la oxidación no solo afecta a los lípidos, sino que también degrada vitaminas (Halbaut et al., 1996), aminoácidos (Helwig, 2020), y xantofilas utilizadas como pigmentos en avicultura y acuicultura (Calabotta and Shermer, 1985), con el consecuente impacto económico.

En consecuencia, la oxidación puede provocar deficiencias nutricionales, reduciendo el rendimiento e incrementando los costes productivos (Shurson et al., 2015; Fellenberg and Speisky, 2015).
No obstante, la pérdida de valor nutricional no es el único mecanismo por el que la oxidación afecta a parámetros productivos. Los compuestos volátiles producidos, como aldehídos y cetonas, provocan olores y sabores desagradables, reducen la palatabilidad y disminuyen el consumo (Qaisrani et al., 2021).

Asimismo, la alimentación con aceites oxidados induce estrés oxidativo en animales de producción, como se ha demostrado en broilers (Lindblom et al., 2019), y cerdos (Lindblom et al., 2018), con efectos negativos sobre el rendimiento.
El estrés oxidativo ocurre cuando especies reactivas de oxígeno (ROS) y radicales libres superan la capacidad de los sistemas antioxidantes endógenos para neutralizarlos, causando daños en lípidos, proteínas y ADN tisular (Kalyanaraman, 2013).
La oxidación de la dieta y el consiguiente estrés oxidativo afectan al sistema inmune y aumentan la predisposición a infecciones. Este impacto incluye la degradación de ácidos grasos esenciales, necesarios para la síntesis de eicosanoides que regulan la inmunidad y la proliferación linfocitaria, así como el daño de las ROS sobre la barrera intestinal.
Además, el exceso de ROS incrementa la demanda de vitamina E y reduce las reservas antioxidantes disponibles para sostener la respuesta inmune (Lauridsen, 2019).
El estrés oxidativo y la degradación de nutrientes causada por el enranciamiento de la dieta pueden incluso aumentar la mortalidad. La depleción de vitamina E por oxidación o su aporte insuficiente favorecen la aparición de la enfermedad de corazón de mora en cerdos (fig. 2), caracterizada por la muerte súbita en animales jóvenes (Pallarés et al., 2002).

2. Fotografía de corazón de cerdo con enfermedad de corazón de mora. Imagen de Oropeza-Moe et al. (2015)
Incluso sin signos clínicos, la alimentación con pienso oxidado puede afectar significativamente al rendimiento.
Gao et al. (2023) demostraron que dietas con 3% de aceite de soja oxidado en lechones alteran la morfología y la función intestinal (fig. 3), reduciendo la relación vellosidad/cripta, la expresión de proteínas de uniones estrechas (ocludina y ZO-1) y la actividad lipasa, además de aumentar la expresión de citoquinas proinflamatorias.
En consecuencia, la salud intestinal y el aprovechamiento de nutrientes se comprometen por la oxidación de la dieta.


Consumo de alimento (g/día)
Figura 3. Imagen adaptada de Gao et al (2023). Morfología intestinal en lechones destetados expuestos a aceite de soja oxidado fresco (FSO) y oxidado (OSO). Aumento original: 200×, barra de escala: 200 μm.




Ganancia media diaria (g/día)
alimento (g/día)
En conjunto, los efectos de la oxidación de la dieta y del consecuente estrés oxidativo afectan a los parámetros productivos. Yaseen et al. (2021) demostraron en broilers que dietas con 5% de aceite de girasol oxidado (valor de peróxidos, PV: 40–60 meq O₂/kg) redujeron significativamente la ingesta, la ganancia media diaria (GMD), el peso de la canal, y empeoraron el índice de conversión (IC).
Ganancia media diaria (g/día)
Con 20 meq O₂/kg también se observó un empeoramiento numérico del rendimiento y significativo en el IC (fig. 4).



Índice de conversión

Estos resultados coinciden con el rango máximo aceptable de PV de 10 a 20 meq O2 /kg, descrito en algunos estudios (Ravindran et al., 2016), y el límite comúnmente aceptado por la industria de 10 meq O2 /kg de grasa. Consumo de alimento (g/día) Ganancia




Figura 4. Parámetros productivos de broilers alimentados con 5 % de aceite de girasol fresco (T1: 1 meq O₂/kg) u oxidados (T2: 20, T3: 40, T4: 60 meq O₂/kg). Datos obtenidos de Yaseen et al. (2021). Letras distintas indican diferencias significativas (P ≤ 0,05; n = 6).
En pollos y pavos, Qaisrani et al. (2021), reportaron que la suplementación con aceite oxidado (PV: 25–448,5 meq/ kg) en niveles del 2–11% durante 0–49 días redujo el consumo entre 1 y 8%, la ganancia media diaria (GMD) entre 0,5 y 8%, y empeoró el índice de conversión (IC) entre 2 y 10%.
En cerdos, múltiples estudios muestran efectos negativos sobre el rendimiento. Una revisión de 16 estudios indicó que dietas isocalóricas con lípidos peroxidados redujeron, en promedio, un 11,4 % la tasa de crecimiento y un 8,8 % el consumo de alimento frente a dietas con lípidos no peroxidados de la misma fuente (Shurson et al., 2015).
Sin embargo , los efectos de una dieta oxidada no se limitan al rendimiento, sino que afectan también la calidad de los alimentos producidos. La alimentación con piensos con grasas oxidadas reduce los ácidos grasos poliinsaturados (Yaseen et al., 2021), α-tocoferol y retinol, disminuye la capacidad de retención de agua, aumenta las pérdidas por exudación (Qaisrani et al., 2021) y reduce la estabilidad oxidativa de la carne de ave (Lin et al., 2007).
En resumen, controlar la oxidación de materias primas, grasas y del alimento final es crucial para evitar efectos negativos sobre el rendimiento, la calidad de la carne, la salud animal y el impacto económico asociado.
Los antioxidantes son la principal herramienta para prevenir la oxidación (Fellenberg & Speisky, 2006), siendo fundamental su utilización para estabilizar grasas, aceites y piensos lo antes posible durante su proceso productivo (Lauridsen, 2019).
En próximos artículos abordaremos las claves para un control eficaz y optimizado de la oxidación, capaz de prevenir sus efectos negativos, a menudo silenciosos, sobre la producción animal.
La oxidación de los piensos reduce su calidad nutricional y energética, afectando rendimiento, eficiencia alimenticia y generando pérdidas económicas.
Las alteraciones organolépticas producidas por la oxidación en piensos reducen el consumo, afectando los índices productivos.
Dietas con grasas oxidadas inducen estrés oxidativo, comprometen la barrera intestinal y debilitan la inmunidad.
La oxidación afecta la calidad de la carne y aumenta pérdidas económicas por exudación y menor estabilidad oxidativa.
El uso de antioxidantes y la estabilización temprana de grasas y piensos es clave para prevenir los efectos negativos, a veces silenciosos, en la producción animal.

La oxidación, amenaza silenciosa de la producción animal DESCÁRGALO EN PDF
Gama de antioxidantes sinérgicos que preservan el valor nutricional, el sabor, el aroma y el color de piensos, premixes y materias primas.

Antioxidante sinérgico que combina BHT/BHA con galato de propilo y quelantes de metales. Formato líquido y polvo.
Fórmula avanzada que une BHT/BHA con compuestos quelantes y potenciadores de acción. Disponible en polvo y líquido.

Equipo técnico Lucta
Cuando se analizan los principales desafíos en producción animal es fácil identificar aquellos factores que pueden suponer obstáculos para la industria en el futuro.
Los cambios continuos en alimentación derivados de la búsqueda de ingredientes alternativos, factores anti-nutricionales como las micotoxinas, patologías intestinales que aún no están bien resueltas (ej.: coccidiosis) y temperaturas extremas propias del cambio climático dificultan la convergencia con el bienestar animal, la eficiencia y la calidad de los productos animales que llegan a la mesa del consumidor.


Además de bioseguridad y una prevención sanitaria óptima, la clave reside en mantener un entorno intestinal libre de procesos inflamatorios y evitar el desequilibrio oxidativo que pueda alterar la función digestiva. Dicho de otro modo, es necesario incrementar la resiliencia para afrontar los continuos cambios.

Los bioactivos del olivo, con una actividad antioxidante y antiinflamatoria bien definida, pueden jugar un papel decisivo en este contexto. LUCTA , una compañía especializada en nutrición animal, ha desarrollado aditivos en base a bioactivos del olivo.

España es el mayor productor de aceitunas y aceite de oliva según los datos del Consejo Internacional del Olivo. Esto supone una generación anual extraordinaria de subproductos derivados de estos procesos (hojas, pulpa, aguas de lavado,…) con el correspondiente riesgo medioambiental.

Los beneficios del aceite de oliva, como pilar de la dieta mediterránea, son bien conocidos:
Protección frente a problemas cardíacos.
Menor incidencia de problemas relacionados con el cáncer.
Una mejora del estatus sanitario intestinal.
Sin embargo, estos subproductos, que también son ricos en bioactivos, pueden convertirse en una fuente potencial y valiosa de compuestos de interés, tanto para la industria cosmética y de alimentación humana como para la industria de aditivos para alimentación animal.
Representan, por tanto, un excelente ejemplo de economía circular.
Estos beneficios se atribuyen no sólo a un perfil de ácidos grasos más saludable, sino también a la presencia de pequeñas moléculas con propiedades antiinflamatorias y antioxidantes.

Entre estas moléculas, los polifenoles (ej.: hidroxitirosol) y los triterpenos policícliclos (ej.: ácido maslínico y ácido oleanólico) son los que más han atraído la atención científica.

¿Cuáles son las causas de la inflamación y el estrés oxidativo sobre la mucosa intestinal y cuáles son las consecuencias para la absorción de nutrientes?
Los animales de interés ganadero están expuestos a factores estresantes en los sistemas de producción actuales. Los factores antinutricionales, cambios en el ambiente, ciertas enfermedades bacterianas y parasitarias, alteraciones inmunológicas, e incluso sociales, pueden disparar o exacerbar diferentes desórdenes fisiológicos -especialmente en el aparato digestivo-.
Estos desórdenes se manifiestan a través de procesos inflamatorios y de estrés oxidativo. Como resultado, la absorción por parte de los enterocitos queda comprometida.
Por otro lado, estas condiciones causan un desequilibrio entre los productos oxidativos generados de forma natural en el organismo (ej.: Especies Reactivas del Oxígeno) y los mecanismos naturales de defensa frente a la oxidación (ej.: catalasa).
El desequilibrio conduce a una concentración excesiva de radicales dañinos dentro de las células con una capacidad de destrucción por encima de la capacidad de los tejidos para regenerarse. Además del daño tisular a nivel intestinal, esto puede contribuir -entre otros factores- al desarrollo de ciertas miopatías que afecten a la calidad de la carne.
El mayor problema es la cronificación del fenómeno inflamatorio, que permanece subclínico en la mayoría de los casos, sin signos evidentes de su presencia.
Esto provoca una reducción del crecimiento, alteraciones en el metabolismo muscular y una activación del sistema inmune. Además, la permeabilidad intestinal también se desequilibra, afectando negativamente a la absorción e incrementando el contenido acuoso de las heces.
Las consecuencias prácticas son una pérdida de eficiencia en la producción y un deterioro del bienestar animal.
Un incremento en la temperatura ambiental puede modificar también los patrones de consumo y la absorción de nutrientes. Por otra parte, durante la fase de estrés, el flujo sanguíneo se desplaza del intestino a la periferia generando hipoxia en las células epiteliales intestinales.
Esta reducción en flujo sanguíneo, junto con un menor tránsito intestinal, afecta a la integridad y a la función de barrera permitiendo que componentes dañinos y microorganismos patógenos pasen del intestino al torrente sanguíneo.

Todo ello lleva asociado un incremento en plasma de marcadores de enterotoxemia, hipoxia e inflamación que van a contribuir a un fallo multiorgánico. Uno de los órganos más afectados es el tracto intestinal y asociados (ej.: hígado).
El uso de ciertos componentes provenientes de la oliva ha demostrado una clara acción antiinflamatoria y antioxidante a través de diversos estudios in vitro, en diferentes modelos celulares, e in vivo.
Existen diferentes marcadores para valorar la salud intestinal. Cada uno de ellos se comporta de forma diferente y proporciona información específica.
Algunos autores han revisado los marcadores más apropiados para esta evaluación.
Citoquina in amatoria(IL-8). Actividad pro-in amatoria
Sistema inmune. El papel de las citoquinas:
Las citoquinas son proteínas específicas que actúan como mediadores de la inflamación, tanto iniciando (pro-inflamatorias) como resolviendo (antiinflamatorias) el proceso.
Diversos estudios in vivo han demostrado la capacidad de los bioactivos del olivo para modular la respuesta inflamatoria local y sistémica. Se ha observado la reducción en la expresión de ciertas citoquinas pro-inflamatorias (IL-8) y un incremento en otras con actividad antiinflamatoria (TGF-β4) tras la inclusión en las dietas de bioactivos del olivo.
Factor de crecimiento transformante (TGF-β4). Actividad anti-in amatoria
Control: Dietas basadas en trigo; Oliva BIO: Bioactivos del Olivo. Herrero-Encinas et al., 2020a (Poult. Sci.).
De forma normal, dentro del organismo se producen radicales libres (R.O.S. = Reactive Oxygen Species) junto con mecanismos que permiten contrarrestar estos agentes oxidantes (Catalasa).
Existen varios factores, como la existencia de micotoxinas en la dieta, calidad deficiente de ciertos ingredientes y estrés calórico, entre otros, que pueden causar un desequilibrio entre los niveles de agentes oxidantes y sus neutralizantes.


Este desequilibrio se conoce como estrés oxidativo y conduce, entre otros efectos secundarios, a un incremento del daño celular.
En determinados estudios in vitro, los bioactivos del olivo han demostrado su capacidad para reducir los niveles de agentes oxidantes e incrementar la expresión de proteínas encargadas de su eliminación, incluso en situación de desafío.
Permeabilidad celular
Gráfica 2. % Inhibición ROS. CON: control; TBHP: Tert-Butyl Hidroperóxido (desafiante); OE: Bioactivos del Olivo.
relativa
Gráfica 3. Expresión relativa catalasa. CON: control; TBHP: Tert-Butyl Hidroperóxido (desafiante); OE: Bioactivos del Olivo; LPS: Lipopolisacáridos (desafiante).
Estudios in vitro llevados a cabo en modelos celulares intestinales (IPEC-J2) han demostrado un efecto positivo de los bioactivos del olivo al incrementar la expresión relativa de las proteínas de las uniones estrechas (ocludinas y claudinas) incluso bajo el efecto de desafíos inmunes (LPS).
Esto podría ayudar a la barrera intestinal a actuar como una verdadera barrera selectiva, permitiendo así, una absorción nutricional efectiva y evitando la entrada de patógenos al torrente sanguíneo.


Expresión relativa
Gráfica 4. Expresión relativa ocludinas. LPS: lipopolisacáridos; OE: Bioactivos de la Oliva.
Gráfica 5. Expresión relativa claudinas. LPS: lipopolisacáridos; OE: Bioactivos de la Oliva.
de las criptas (µm)
CF: control; OED1: Bioactivos Oliva baja dosis; OED2: Bioactivos de la oliva alta dosis; MF: monensina 100 ppm. Herrero-Encinas et al., 2020b (Animals) P valor <0,014
Gráfica 6. Profundidad de las criptas.
Desde una perspectiva histológica, la profundidad de las criptas está relacionada directamente con el daño producido en las células intestinales.
Los intestinos dañados muestran un incremento de la profundidad de las criptas como signo de renovación celular asociada al daño. Disminuciones de la profundidad suelen asociarse a una mejor homeostasis intestinal con mejoras en la absorción de nutrientes.
Diversos estudios llevados a cabo por LUCTA muestran una reducción de la profundidad de las criptas en pollos con dietas suplementadas con bioactivos del olivo y que habían sido desafiados con un periodo largo de ayuno. Esto evidencia la protección de las células intestinales mediante el suplemento de bioactivos del olivo.

Vellosidad
Proliferación Profundidad de las criptas Absorción Longitud de las vellosidades
La reducción del estatus inflamatorio de los animales tiene consecuencias positivas que, en general, se acaban traduciendo en una mejor absorción intestinal de los nutrientes y el agua.
Esto no sólo supone una mejora de los resultados zootécnicos, sino que también contribuye a evitar problemas específicos, como las camas húmedas, muy estrechamente relacionados con el bienestar animal.
Los bioactivos del olivo, por tanto, se posicionan como una herramienta prometedora en aquellas estrategias dirigidas a mejorar la resiliencia y el bienestar de los animales, así como la calidad de los productos avícolas y ganaderos.
Referencias bibliográficas disponibles en la versión web del artículo

El olivo, pilar de la dieta mediterránea, como estrategia para la mejora de la integridad intestinal
DESCÁRGALO EN PDF




Departamento técnico grupo PH-Albio
Todos sabemos que cualquier estrategia planteada para afrontar los desafíos diarios de nuestras explotaciones, si se centra en un solo aspecto de la producción animal, siempre estará incompleta.
El manejo, la bioseguridad, la nutrición, la genética y las instalaciones son como engranajes que deben funcionar en conjunto para que las explotaciones sean eficientes y sostenibles en el tiempo.
La prohibición del uso de antibióticos como promotores de crecimiento (AGP) (2006), la limitación del óxido de zinc (2022) y un control cada vez más estricto sobre el uso de antibióticos para tratamientos a nivel de granja, ha provocado que, hoy en día, la nutrición sea haya convertido en una herramienta polivalente.


El objetivo, es que además de mejorar los parámetros productivos, la nutrición sea una alternativa más para garantizar el bienestar de los animales, mejorar la salud intestinal y reducir la dependencia de tratamientos.


Un claro ejemplo de productos que, por sus propiedades, se han posicionado como alternativa sólida a los AGP, son: los ácidos orgánicos, los ácidos grasos de cadena corta y media, y compuestos bioactivos de origen vegetal.
Cada uno de estos aporta un mecanismo de acción específico, y al combinarse, generan un efecto sinérgico que reduce la presión de patógenos, refuerza la salud intestinal y mejora el rendimiento productivo.
El uso de ácidos orgánicos en la nutrición animal se ha consolidado desde hace décadas, por su función como conservantes de materias primas y piensos.
Su papel más extendido es el de inhibir el crecimiento de bacterias, levaduras y hongos en las materias primas y en el pienso final, lo que reduce las pérdidas de nutrientes y garantiza una mayor seguridad durante el almacenamiento.
Entre los más estudiados, el ácido fórmico ha mostrado actividad frente bacterias como Salmonella y Escherichia coli, mientras que el ácido propiónico es especialmente efectivo contra hongos. En conjunto, ambos contribuyen a mejorar la higiene de las materias primas y los piensos, reduciendo el riesgo de recontaminación durante el almacenamiento.
Pero los beneficios de los ácidos orgánicos pueden ir más allá de la simple conservación del alimento.
Estos compuestos reducen el pH del pienso, creando un entorno menos favorable para patógenos y más adecuado para la digestión

La acidificación favorece la actividad enzimática, mejora la absorción de nutrientes y ayuda a mantener la integridad de la mucosa intestinal. En este sentido, los ácidos orgánicos se consideran aditivos multifuncionales:
Mejoran la seguridad del alimento, apoyan los procesos digestivos y, de forma indirecta, refuerzan la salud intestinal y la productividad del animal.
El aparato digestivo es uno de los sistemas más sensibles y al mismo tiempo más determinantes en la producción animal.
Su estado de salud no solo condiciona la eficiencia con la que el animal aprovecha los nutrientes, sino que también influye en su resistencia frente a enfermedades.

Cuando el intestino pierde integridad, se multiplican los trastornos digestivos, aumenta la vulnerabilidad a infecciones y se reduce la conversión alimenticia, con consecuencias que afectan al bienestar y a la productividad global.
En este contexto, los ácidos grasos de cadena corta (SCFA) y de cadena media (MCFA) han adquirido un papel fundamental. El ácido butírico, por ejemplo, es probablemente el más estudiado dentro de este grupo. Sus principales beneficios incluyen:
Disminuir la colonización por bacterias enteropatógenas
Modular la respuesta inmunitaria
Proporcionar energía directa a los enterocitos
Estimular la regeneración de la mucosa intestinal
Fortalecer las uniones celulares y la estructura de las vellosidades
Existen numerosas publicaciones que muestran que la inclusión de SCFA en la dieta refuerza la integridad intestinal y contribuye a una respuesta inmune más eficaz.
De esta forma, se consolidan como una herramienta capaz de sustituir el papel que antiguamente desempeñaban los antibióticos promotores de crecimiento, ofreciendo beneficios duraderos en términos de integridad intestinal y productividad.
La producción animal moderna se ha beneficiado del conocimiento ancestral de la fitoterapia.
Los compuestos bioactivos de origen vegetal constituyen un grupo amplio de metabolitos producidos por las plantas como defensa frente a depredadores, infecciones o estrés ambiental.

Estas mismas propiedades pueden aprovecharse en nutrición animal para mejorar la integridad intestinal, modular la microbiota y reforzar el sistema inmunitario de los animales.

Los compuestos bioactivos se clasifican según la parte de la planta y el método de obtención, y pueden presentarse como:
Aceites esenciales: fracciones volátiles obtenidas por destilación, ricos en terpenos y fenoles con reconocida acción antimicrobiana.
Extractos vegetales: obtenidos por maceración, concentran metabolitos en solución.
Oleorresinas: muy utilizadas en especias, con alta concentración de compuestos activos.


Una característica clave de los productos vegetales es que rara vez actúan de forma aislada.
Las mezclas poli herbales combinan múltiples metabolitos secundarios que interactúan de manera sinérgica y potencian a los fitoquímicos principales.
Esta interacción explica por qué determinadas combinaciones de extractos vegetales pueden generar respuestas más eficientes y multifuncionales que la suma de sus principios activos por separado.
Productos herbales: preparados simples (secado, triturado, molienda) que preservan la planta completa.
La clasificación también puede hacerse según los principales compuestos fitoquímicos predominantes: fenoles (flavonoides), terpenos, saponinas, etc.
Cada uno presenta propiedades particulares que abarcan desde la estimulación del sistema inmune hasta efectos antimicrobianos o hepatoprotectores.

No obstante, la eficacia real de cada producto depende de múltiples factores: vegetal utilizada, la parte de la planta de donde se obtiene, el método de extracción aplicado y, sobre todo, el grado de estandarización del proceso.
Dos extractos derivados de la misma planta pueden presentar perfiles químicos muy diferentes y, en consecuencia, producir efectos biológicos variables.
En conjunto, los compuestos bioactivos de origen vegetal representan una de las alternativas más prometedoras en la nutrición animal moderna.
Su potencial recae en la riqueza de fitoquímicos que contienen y en la compleja red de interacciones que estos pueden establecer.
Esto les otorga un potencial multifuncional para mejorar la integridad intestinal, optimizar la absorción de nutrientes y contribuir al control de desafíos relevantes en nuestros animales.
La producción animal actual se enfrenta al gran desafío de mantener la competitividad en un entorno en el que el uso de antibióticos está cada vez más restringido.
En este escenario, la combinación de ácidos orgánicos, SCFA y MCFA junto con compuestos bioactivos vegetales aparece como una de las estrategias más completas y efectivas disponibles.
Uso de ácidos orgánicos, ácidos grasos y extractos de plantas en nutrición animal
DESCÁRGALO EN PDF
Cada herramienta aporta beneficios concretos:
Los ácidos orgánicos (ácido fórmico, ácido propiónico y ácido acético) mejoran la higiene y la estabilidad del pienso, reduciendo riesgos de contaminación y refuerzan la salud intestinal y la productividad del animal
Los SCFA y MCFA (ácido butírico, ácido caprílico y ácido cáprico) refuerzan la integridad intestinal.
Los compuestos vegetales bioactivos ofrecen múltiples efectos versátiles.
En Grupo PH-Albio contamos con más de 35 años de experiencia ofreciendo soluciones eficaces y competitivas, que incluyen, entre otras, la combinación de ácidos y fitoquímicos, para abordar los desafíos a los que hace frente la producción animal.

Un claro ejemplo de ello es BiCidal®, que nació de años de investigación. BiCidal® es una mezcla sinérgica de diferentes ácidos orgánicos y bioflavonoides y ha demostrado tener actividad antimicrobiana, tanto en pruebas de laboratorio, como en pruebas “in vivo” y en condiciones reales de campo.




Departamento de MK Técnico de Andrés Pintaluba
La proteína constituye el nutriente central en la nutrición animal, siendo determinante para el crecimiento, la salud y el rendimiento productivo de las especies de interés zootécnico.
Tradicionalmente, las dietas se han formulado a partir de materias primas de origen vegetal, como la soja y sus derivados, y de origen animal, como la harina de pescado o el plasma.
Sin embargo, estas fuentes presentan limitaciones importantes:
Variabilidad en la calidad
Factores antinutricionales
Fuerte dependencia de mercados internacionales sujetos a volatilidad de precios y tensiones geopolíticas
A ello se suman los desafíos ambientales asociados a la producción intensiva de cultivos y a la presión sobre los ecosistemas acuáticos.


En este contexto, la identificación de fuentes proteicas sostenibles, seguras y con funcionalidades nutricionales específicas se ha consolidado como una prioridad en el ámbito de la nutrición animal.
Entre las alternativas emergentes con mayor potencial destacan dos ingredientes desarrollados recientemente:
Ambas fuentes proteicas aportan ventajas diferenciales que, además, pueden complementarse de forma sinérgica, abriendo la puerta a una n ueva concepción en la nutrición animal basada no solo en la cobertura de requerimientos nutricionales, sino también en la optimización de la salud intestinal y de la eficiencia metabólica.
Además, al derivar de diferentes procesos productivos y constituir subproductos, su incorporación permite un uso más eficiente de los recursos dentro de un enfoque de economía circular, reforzando la sostenibilidad de la producción.
Concentrado de mucosa intestinal porcina hidrolizada

Concentrado de biomasa de Corynebacterium glutamicum
El hidrolizado obtenido a partir de mucosa intestinal porcina constituye una fuente proteica funcional de alto valor.
Su obtención se basa en un proceso de hidrólisis controlada, seguido de concentración, pasteurización y secado, lo que garantiza la estabilidad microbiológica y oxidativa del producto.
La hidrólisis a la que se somete la mucosa durante su procesamiento, genera péptidos de cadena corta con un bajo peso molecular que constituyen cadenas de 3 a 35 aminoácidos, con masas de entre 500 y 5.000 Dalton.
Se absorben más fácilmente que la proteína intacta o incluso que los aminoácidos libres, reduciendo la carga digestiva y favoreciendo una rápida disponibilidad de nitrógeno proteico.
Estos péptidos bioactivos derivados de la hidrólisis actúan como inmunoestimuladores, refuerzan la integridad de la mucosa intestinal y promueven un aumento de la altura de las vellosidades.
Favorecen una mejor relación vellosidad/ cripta, incrementando de este modo la capacidad absortiva de los nutrientes.
de pienso residual en el comedero
Además, el concentrado hidrolizado presenta una alta apetencia y palatabilidad, tal y como como lo evidencian ensayos de elección en los que resultó más atractivo para los lechones que diversas alternativas sensoriales, favoreciendo así un arranque más rápido y homogéneo tras el destete (Gráfica 1).
de mucosa
Gráfica 1. Evolución del consumo de pienso en lechones: comparación entre mucosa intestinal porcina hidrolizada y aditivos aromatizantes comerciales. Fuente interna.
En ensayos con lechones en la Universidad Estatal de Iowa, la sustitución parcial de harina de soja por hidrolizado de mucosa mejoró la ganancia diaria y el consumo sin efectos adversos en la tolerancia (Zimmerman et al., 1997).

Ensayos histológicos mostraron un altura de vellosidades intestinales y una mejor relación vellosidad/cripta en lechones suplementados, lo que se traduce en mayor capacidad de absorción (Corassa et al., 2007).

Estudios de la Universidad de Kansas demostraron que su uso como sustituto parcial del plasma o de la harina de pescado en dietas prestarter mantuvo o mejoró los resultados productivos, con mejor uniformidad de los lotes (Angulo et al., 2001; Myers et al., 2010).
Se observó además un incremento en la actividad enzimática digestiva y en la deposición muscular, indicando que los péptidos hidrolizados favorecen el desarrollo metabólico y productivo (Xin et al., 2001).

La biomasa bacteriana obtenida mediante la fermentación de Corynebacterium glutamicum, representa una fuente innovadora de proteína no animal con características nutricionales y tecnológicas muy atractivas.
Se produce mediante fermentación controlada, un proceso que desvincula su disponibilidad de la superficie agrícola cultivable o de la estacionalidad pesquera.
Esto asegura un suministro constante, estable en calidad y menos vulnerable a factores externos.
Este ingrediente se distingue por su proteico, con aproximadamente un 70 de proteína bruta, un perfil de aminoácidos equilibrado y especialmente rico en ácido glutámico.
En porcino, la inclusión de biomasa de C. glutamicum como sustituto parcial del plasma sanguíneo mejoró la ganancia media diaria de lechones sin comprometer la digestibilidad (Yi-Chi Cheng et al., 2021).
En vacuno lechero, su sustitución de hasta un 60% de harina de soja redujo el coste de la dieta hasta un 17% y aumentó la rentabilidad láctea un 33%, sin efectos negativos sobre la digestibilidad o producción (Padunglerk et al., 2016)

En pequeños rumiantes, su uso incrementó la ganancia de peso y la digestibilidad de la proteína cruda (Rukboon et al., 2018).
Presenta un bajo peso molecular, con alrededor del 65 % de las fracciones proteicas de tamaños inferiores a 500 Dalton, constituidas por péptidos muy cortos (1 a 3 aminoácidos), lo que favorece significativamente la digestibilidad y la absorción intestinal.
Asimismo, su bajo contenido en cenizas facilita la formulación de dietas sin generar desajustes electrolíticos. Del mismo modo, el notable aporte de nucleótidos resulta especialmente relevante en fases que implican estrés adicional, como el destete en lechones, al reforzar la inmunidad local.
En acuicultura, mostró mejor conversión alimenticia que fuentes vegetales e insectos (do Vale Pereira et al., 2024).


HIDROLIZADA Y BIOMASA PROTEICA DE CORYNEBACTERIUM GLUTAMICUM
La combinación de ambos concentrados proteicos en una misma dieta, no solo integra las ventajas nutricionales de cada fuente, sino que también genera beneficios prácticos y fisiológicos adicionales.
Cobertura nutricional más completa: eficiencia en el uso de aminoácidos y diversidad funcional

La inclusión de mucosa intestinal porcina con su perfil de aminoácidos más cercano a la proteína ideal de cerdos, junto con biomasa proteica de Corynebacterium glutamicum constituye una estrategia nutricional avanzada que facilita la formulación de dietas balanceadas y optimiza la utilización proteica.
La combinación de estas fuentes permite complementar los aminoácidos limitantes de las fuentes convencionales, lo que maximiza la eficiencia de síntesis proteica.
Asimismo, se potencia la digestibilidad global y la absorción de aminoácidos, ya que la mucosa aporta proteínas completas de origen animal mientras que la biomasa microbiana proporciona péptidos de bajo peso molecular de rápida disponibilidad.

Mejora de la salud intestinal y la respuesta inmune

Los nucleótidos presentes en la biomasa de Corynebacterium glutamicum contribuyen a reforzar la inmunidad, fortaleciendo la capacidad de respuesta frente a desafíos patógenos.
Al mismo tiempo, los péptidos bioactivos derivados de la hidrólisis de la mucosa promueven la funcionalidad intestinal al optimizar la estructura epitelial y aumentar la superficie disponible para la absorción de nutrientes.
La acción conjunta de estos componentes se traduce en una menor incidencia de diarreas y en una mayor resiliencia durante etapas críticas como el destete.
y seguridad
La sustitución de la soja y la harina de pescado por estos concentrados contribuye a mitigar la presión sobre los recursos naturales y reduce la dependencia de la producción primaria, asegurando una disponibilidad constante y predecible de los ingredientes.

Ambos materiales presentan un perfil seguro y estandarizado, exento de factores antinutricionales, lo que garantiza su aplicación confiable en formulaciones nutricionales avanzadas y contribuye a la consistencia y reproducibilidad de los efectos en el desempeño animal.
Este enfoque sinérgico mejora la eficiencia de utilización de la proteína, disminuye el desperdicio y reduce la excreción de nitrógeno, favoreciendo un aprovechamiento más eficaz de los nutrientes y contribuyendo a un mejor rendimiento productivo y a la sostenibilidad de la dieta.
Alternativas proteicas para una nutrición sostenible: Explorando el potencial sinérgico de los concentrados proteicos no convencionales
DESCÁRGALO EN PDF
La mucosa intestinal porcina hidrolizada y biomasa proteica de Corynebacterium glutamicum representan dos alternativas de alto valor en nutrición animal.
Gracias a las características de cada una, su empleo conjunto constituye una estrategia innovadora que combina nutrición de alta calidad con funcionalidad intestinal, eficiencia productiva y sostenibilidad ambiental.
La evidencia científica disponible respalda la eficacia de ambas fuentes y su complementariedad, posicionándolas como herramientas estratégicas para la nutrición animal moderna.
Altamente apetente y de gran valor nutricional
Elevado contenido en péptidos bioactivos de alta digestibilidad










Ana de las Heras Molina Universidad Complutense de Madrid




El estrés oxidativo en la etapa perinatal es muy relevante. Así, durante el último tercio de gestación y la lactación, la cerda tiene una gran demanda metabólica, lo que provoca una gran síntesis de radicales libres que se relacionan con un empeoramiento de los índices reproductivos (Berchieri-Ronchi et al., 2011; Zhang et al., 2020).
Por otro lado, el nacimiento supone pasar de un ambiente bajo en oxígeno (el útero) a un ambiente hiperoxigénico, dando lugar a un estrés oxidativo al que el lechón no puede hacer frente, puesto que sus defensas antioxidantes son todavía muy limitadas (Jain, 2016).
La vitamina E (VE) es el antioxidante liposoluble más importante en producción porcina. La suplementación con VE durante el período perinatal es especialmente crítica, puesto que su paso a través de la placenta es muy limitado y se almacena principalmente en la grasa. Por tanto, los lechones nacen con un gran déficit de esta vitamina (Lauridsen et al., 2002).
Por ello, es fundamental encontrar estrategias que controlen los niveles de radicales libres en la etapa perinatal del lechón. En la producción porcina actual, el uso de antioxidantes en las dietas maternas supone una forma efectiva y rentable de controlar el estrés oxidativo de los lechones (Cottrell et al., 2015). Entre las sustancias utilizadas, destacan las vitaminas, los minerales y los polifenoles.

La suplementación materna con VE se debe comenzar durante el último tercio de gestación, momento en el cual se produce tanto un aumento de la demanda fetal de nutrientes como una preparación de la madre al parto. Diversos estudios evidencian los efectos positivos de la VE en el desarrollo de la descendencia tanto en cerdos de capa blanca como en el cerdo Ibérico.
En capa blanca, dosis altas de VE (250 mg/kg) mejoraron el peso de los lechones al destete, así como su sistema inmune y antioxidante (Wang et al., 2017). En el caso del cerdo ibérico, dosis de 100 mg/ kg de VE en dietas maternas se han relacionado con mejores datos morfológicos de la descendencia (Gómez et al., 2023).
Además, a nivel molecular se ha comprobado que en el tejido adiposo, la suplementación materna con VE disminuyó la expresión de genes relacionados con la inflamación y el estrés oxidativo (Laviano et al., 2023).
Otra vitamina de interés en producción porcina es la C (VC). La VC es capaz de devolver la capacidad antioxidante a la VE y de eliminar radicales en diferentes fluidos extracelulares (Traber & Stevens, 2011), habiéndose demostrado que la suplementación conjunta de VE y VC tiene efectos beneficiosos a nivel perinatal en lechones (Pinelli-Saavedra & Scaife, 2005; Sosnowska et al., 2011).
Los minerales como el cobre, el zinc, el hierro o el selenio tienen un gran potencial como antioxidantes al ser parte de diferentes enzimas antioxidantes. Así, tanto el cobre como el zinc forman parte de la superóxido dismutasa (Cu/ Zn SOD), que es capaz de neutralizar el estrés oxidativo mediante la eliminación de radicales libres (Esmaeili et al., 2019; Ho, 2004).

Uno de los minerales más utilizados como suplemento en dietas maternas porcinas es el selenio. Su actividad está principalmente ligada a la enzima glutatión peroxidasa, que tiene un gran poder antioxidante (Liu et al., 2021). Si bien hay investigaciones que apuntan a un efecto sinérgico entre la VE y el selenio en porcino (Shastak & Pelletier, 2025), no se ha visto esta interacción entre ambos antioxidantes cuando se buscan efectos indirectos en la progenie (Chen et al., 2016).
De este modo, parece tener una mayor relevancia el origen del selenio (orgánico vs inorgánico), con mejores resultados si se usa selenio orgánico (Chen et al., 2016).
Los polifenoles comprenden una gran variedad de compuestos secundarios del metabolismo de las plantas. Estos se dividen en dos grandes grupos (flavonoides y no flavonoides) y poseen una gran capacidad antioxidante (Chen et al., 2022; Durazzo et al., 2019).
Por ello, su uso en dietas de gestación y lactación porcina está despertando un gran interés en el sector. Los polifenoles más usados en ganado porcino son la daidceína, la genisteína, la silimarina, la catequina, el garcinol y el hidroxitirosol.
Diversos estudios apuntan a la utilidad de los polifenoles para mejorar el estatus antioxidante y la salud de madres y lechones. Así, estas sustancias fueron capaces de disminuir los niveles de lipooxidación del organismo.
Además, también aumentaron la actividad de enzimas antioxidantes como la glutatión peroxidasa o superóxido dismutasa, incrementando la capacidad antioxidante total de las cerdas.



La mejora de la salud oxidativa de las madres obtenida con la suplementación con diferentes polifenoles también se vio reflejada en la camada, aumentando el número de nacidos vivos, la supervivencia de la descendencia y mejorando sus tasas de crecimiento en los primeros días de vida (Chen et al., 2022).
En conclusión, si bien el exceso de radicales libres en la etapa perinatal puede suponer un problema para la producción porcina, existen diferentes estrategias nutricionales para mejorar el estatus antioxidante de los lechones a través de la nutrición materna.
En la actualidad, se están llevando diferentes estudios para ajustar las dosis y dar con posibles combinaciones de antioxidantes que ayuden a mejorar la salud del lechón en sus primeros días de vida.
Suplementación perinatal: una herramienta práctica para reducir el estrés oxidativo en porcino




Owusu1, Esiosa F. Adewale2, Precious Adedayo Adesina3, Tolulope Peter Saliu4, Zhendong Zhu5, Christian Xedzro6, Emmanuel
Asiamah1 y Shahidul Islam1
1Departamento de Agricultura, Universidad de Arkansas en Pine Bluff, EE.UU.
2Departamento de Biología, Universidad de Louisville, EE.UU.
3Centro Nacional para el Avance de las Ciencias Traslacionales, División de Innovación Preclínica, Institutos Nacionales de Salud, EE.UU.
4Departamento de Fisiología, Facultad de Medicina, Universidad de Kentucky, EE.UU.
5Facultad de Ciencia y Tecnología Animal, Universidad Agrícola de Qingdao, China
6Laboratorio de Microbiología e Higiene Alimentaria, Universidad de Hiroshima, Japón

La salud reproductiva es uno de los pilares fundamentales para la productividad ganadera y la sostenibilidad de los sistemas de producción animal. Sin embargo, su integridad puede verse comprometida por una combinación de factores infecciosos, ambientales y nutricionales.

En este contexto, los extractos fitogénicos —compuestos bioactivos derivados de plantas medicinales— han adquirido relevancia como herramientas naturales capaces de modular procesos fisiológicos complejos implicados en la reproducción, especialmente a través de la regulación hormonal, la respuesta inmunitaria y la mitigación del estrés oxidativo (1–4)

Los fitogénicos comprenden una amplia variedad de compuestos bioactivos como flavonoides, terpenos, polifenoles, saponinas, aceites esenciales y vitaminas naturales.
Entre ellos destacan sustancias como quercetina, kaempferol, gingerol, catequinas, eugenol y carvacrol, con capacidad de modular rutas metabólicas, enzimáticas e inmunológicas tanto en humanos como en animales5,16,17
Este artículo explora los mecanismos por los cuales estos extractos mejoran la función reproductiva, con especial énfasis en la evidencia generada en la especie porcina.
En el contexto ganadero, se han utilizado para:
Mejorar la digestibilidad y absorción de nutrientes al modificar la microbiota intestinal y estimular la secreción enzimática22,23.
Reducir el estrés oxidativo y la inflamación mediante la neutralización de ROS y la inhibición de vías como NFκB17,24.

Estimular funciones endocrinas y reproductivas al interactuar con receptores hormonales o influir en la esteroidogénesis18,25
Además de su efecto directo sobre la salud reproductiva, estos compuestos contribuyen al bienestar general del animal, favoreciendo la recuperación posparto, la eficiencia alimentaria y la calidad del producto final.
REGULACIÓN HORMONAL E IMPACTO EN LA FISIOLOGÍA REPRODUCTIVA

El éxito reproductivo depende de un equilibrio delicado entre estímulos hormonales e integridad estructural de los tejidos reproductivos, y las fitomoléculas pueden influir en este equilibrio a distintos niveles.
La quercetina ha demostrado estimular la liberación de FSH en modelos porcinos, promoviendo la maduración folicular y la ovulación de forma dosisdependiente25
En verracos, el ginseng mejora la secreción de testosterona y la concentración espermática, lo que sugiere una acción androgénica que favorece la espermatogénesis20
Estas evidencias reflejan que los extractos vegetales pueden mimetizar o potenciar acciones hormonales naturales, ofreciendo nuevas estrategias para el manejo reproductivo.
En condiciones normales, el estrés oxidativo forma parte de procesos fisiológicos como la capacitación espermática o la ovulación, pero su exceso puede causar disfunción mitocondrial, fragmentación del ADN y apoptosis en gametos y tejidos reproductivos10–12.
Asimismo, la inflamación crónica, resultado de infecciones persistentes o condiciones de manejo inadecuadas, desencadena la liberación de citoquinas como TNF-α, IL-1 y IL-8, afectando el desarrollo ovocitario y embrionario13-15
Algunos fitogénicos actúan neutralizando ros y modulando la producción de mediadores inflamatorios
Por ejemplo, en células intestinales porcinas (IPEC-J2), un aditivo fitogénico redujo significativamente la producción de ROS inducida por peróxido de hidrógeno y suprimió la activación del NF-κB, con descenso paralelo de IL-6 e IL-824.
Esta acción dual antioxidante e inmunorreguladora es especialmente relevante en cerdas hiperprolíficas o sometidas a estrés térmico, donde el equilibrio redox es determinante para mantener la función ovárica y uterina.
HiPhorius™
Ronozyme® HiPhos
Ronozyme® WX

Ronozyme® MultiGrain
Ronozyme® VP
Balancius®
Chr. Hansen y Novozymes se han unido para convertirse en Novonesis, lo que es una buena noticia para el sector porcino. Con el banco de cepas comercial más grande del mundo y un conocimiento técnico sin igual, seleccionamos científicamente cepas probióticas para favorecer la salud de los cerdos y optimizar la rentabilidad del pienso. Como líder mundial en biosoluciones, Novonesis ha adquirido el negocio de enzimas para alimentación animal de dsm-firmenich integrando ahora, bajo un mismo techo, las ventas y distribución con la innovación y producción de Novonesis, ofreciéndote lo mejor de ambos mundos en biosoluciones. Hablemos sobre el rendimiento de tus animales.
Visita novonesis.com

FITOGÉNICOS EN ACCIÓN: EFECTOS
DEMOSTRADOS EN CERDOS
La especie porcina ha sido protagonista de varios ensayos que destacan el potencial de los fitogénicos en salud reproductiva.

Salud intestinal y absorción de nutrientes
La administración de extractos de Allium (ajo y cebolla) en dietas de cerdos mejoró la ganancia media diaria y la digestibilidad, reduciendo la presencia de patógenos como Salmonella y Clostridium, y aumentando la población de Lactobacillus23
Esta mejora en la salud intestinal tiene un impacto positivo indirecto sobre la reproducción al facilitar una mayor biodisponibilidad de nutrientes esenciales para la función endocrina y gametogénica.
En esperma porcino criopreservado, el extracto acuoso de Rhodiola sacra mejoró la motilidad y la integridad funcional del acrosoma, reduciendo los niveles de peroxidación lipídica y mejorando la calidad bioquímica del plasma seminal19
Esto abre la puerta a nuevas soluciones para mejorar la eficiencia de la inseminación artificial.
La suplementación dietética con ginseng ha demostrado mejorar significativamente la concentración espermática, la viabilidad y los niveles de enzimas antioxidantes en verracos, indicando una mejora integral de la salud testicular20
Pese a sus múltiples beneficios, ciertos extractos pueden presentar efectos adversos si se utilizan en dosis inadecuadas o en formulaciones no validadas.
Fitotóxicos sobre espermatozoides
Algunos extractos como los de Thymbra capitata y Rosmarinus officinalis han mostrado efectos citotóxicos sobre espermatozoides porcinos in vitro, reduciendo su motilidad y funcionalidad mitocondrial a concentraciones elevadas31,32, lo que pone de manifiesto la importancia de evaluar con rigor las dosis y vías de administración.


Una 1,4-beta glucanasa
MAX
Una altamente eficiente 1,4-betaxilanasa
Un xiloglucano específico 1,4-betaglucanasa
ACE
JUNTOS, NOSOTROS SOMOS
Y nos aseguramos de que los animales aprovechen al máximo la fibra, asegurando un rendimiento optimizado y un intestino saludable.
Interacciones hormonales no deseadas
Ciertos fitoestrógenos, como la genisteína o la daidzeína, pueden interferir con la biosíntesis de estradiol, alterar la esteroidogénesis o inducir anestro y quistes ováricos si se administran en exceso26-30
En cerdas, esto podría traducirse en fallos de implantación, acortamiento de la vida útil reproductiva o infertilidad funcional.
Acumulación de residuos
Se han detectado metabolitos de compuestos como carvacrol y timol en sangre y riñones de cerdos suplementados con PFAs, lo que plantea interrogantes sobre la seguridad de residuos en productos de origen animal, aunque no se ha demostrado toxicidad32
La falta de límites máximos de residuos oficialmente establecidos constituye un desafío regulatorio importante.
Aunque la evidencia disponible es prometedora, aún quedan aspectos por resolver para una implementación eficaz en la especie porcina:
1
Estandarización de formulaciones
La composición fitoquímica puede variar según el origen vegetal, el método de extracción y la dosis, lo que dificulta la reproducibilidad de los resultados21.
2
Evaluaciones a largo plazo
La mayoría de estudios en cerdos son de corto plazo o in vitro, requiriéndose ensayos longitudinales que midan variables como tasa de concepción, fertilidad, duración del intervalo destete-celo y tamaño de camada.
3
Interacción con otras estrategias nutricionales
La combinación con prebióticos, minerales traza o programas vacunales puede potenciar o antagonizar los efectos deseados, lo que obliga a estudiar sinergias e interferencias.
4
Consideraciones regulatorias
La ausencia de límites de seguridad, protocolos de registro y validación normativa limita el uso comercial de ciertos extractos en la alimentación porcina.
Los fitogénicos representan una herramienta biológicamente activa con un potencial significativo para mejorar la salud reproductiva porcina.
Su capacidad para modular el estrés oxidativo, las vías inflamatorias y el eje endocrino, sumada a sus efectos sobre la microbiota y la absorción de nutrientes, los sitúa como candidatos prometedores en programas de reproducción sostenibles.
Su implementación exige precaución, rigor científico y una comprensión detallada de sus mecanismos de acción y efectos dosis-dependientes. La integración efectiva de los fitogénicos en la práctica porcina dependerá de la colaboración entre investigadores, nutricionistas, veterinarios y entidades regulatorias.
En un momento en que la productividad debe ir de la mano con la sostenibilidad y el bienestar animal, estas moléculas naturales nos invitan a mirar la fisiología desde una óptica más integradora, respetuosa y adaptativa.
Artículo elaborado a partir del artículo original “Owusu, E.F., Adewale, P.A., Adesina, T.P., Zhu, Z., Xedzro, C., Asiamah, E., & Islam, S. (2025).
Phytogenic Extracts and Reproductive Health: A Molecular Perspective. Frontiers in Veterinary Science, 12:1568577”, centrando la atención en los aspectos más relevantes para la especie porcina.
Referencias disponibles en la versión web del artículo en nutrinews.com

Potencial de los extractos fitogénicos en salud reproductiva: una mirada molecular con foco en la especie porcina DESCÁRGALO EN PDF
Grandía J.1, Sarasa R.2, Bruguera M.3 y García, A.3
1Agro-Test-Control. C/Poeta León Felipe, local 7-9. 50018 Zaragoza (España).
2Inneara consultoría. C/Poeta León Felipe, local 7-9. 50018 Zaragoza (España).
3 Agrifirm. Avenida Monte Boyal, 91, 94, 45950, Casarrubios del Monte, Toledo (España).


INTRODUCCIÓN
El destete supone una fase muy crítica en la vida productiva del lechón, con diversos factores que le causan estrés social, ambiental y alimentario, lo que compromete su estatus sanitario, su buen funcionamiento fisiológico y, en consecuencia, el buen desarrollo de sus parámetros productivos.
Por este motivo, los lechones a menudo muestran una reducción del crecimiento y son más susceptibles a enfermedades. Debido a que su sistema digestivo todavía está inmaduro, la proteína no digestible llega al intestino grueso por lo que está disponible para las bacterias patógenas, causando inflamación y estrés oxidativo.

Si se consigue reducir este estrés oxidativo a todos los niveles se puede conseguir obtener animales más sanos, con mayor bienestar y un mejor rendimiento.

El objetivo era demostrar la eficacia del producto Vitanox como antioxidante en base a polifenoles naturales en lechones en transición, protegiendo de este modo los enterocitos frente a la oxidación y preservando así la integridad de la barrera intestinal.
Se buscaba también demostrar el efecto del producto en la mejora del estado sanitario intestinal a fin de impedir posibles pasos de gérmenes al sistema circulatorio, potenciando el estado inmunitario del lechón y su preparación para diferentes desafíos (patógenos) (Scott A. Dee, 2020).
En una explotación positiva a PRRS, confirmada por pools de suero sanguíneo de 5 animales recién destetados y análisis por PCR, se seleccionaron 1.110 animales distribuidos en 24 corrales (555 animales en 12 corrales en cada grupo control y prueba).
Durante la fase de transición, se registraron los siguientes parámetros productivos: peso por corral (a la entrada de los animales, al cambio de pienso pre-starter a starter y al final de transición), control de bajas y consumos por corral. Con estos datos se calculó la ganancia media diaria (GMD) e índice de conversión (IC) por corral.
También se llevó a cabo un exhaustivo plan de control de calidad de las heces mediante inspección visual: de manera diaria hasta 5 días post cambio de dieta (tanto al inicio de la prueba como al cambio pre-starter al starter), y posteriormente cada dos días durante el resto de la prueba.
Además, se realizó necropsia de 1 animal por corral (12 animales por grupo, 24 en total) al final de transición para la observación macroscópica del intestino y órganos (hígado) y el estudio de longitud de vellosidades, profundidad de criptas y ratio.
Por otro lado, en laboratorio se realizó el análisis de medición del índice de oxidación de proteínas (ROS y TBARS; Carl A Frame, 2020) como indicadores del estrés oxidativo, y análisis de ocludina (Nienke de Groot, 2021) por qPCR con química SYBRgreen normalizada con beta-actina. Para el cálculo numérico de expresión génica se utilizó los cálculos de Livak; doble deltaCt y un Log2 de resultado.
Por último, en 1 animal por corral (en total 24 animales, 12 por grupo), diferentes a los del estudio anterior, se realizó un estudio de medición de la permeabilidad intestinal mediante ovoalbúmina. La prueba consistía en introducir una cantidad exacta y conocida de ovoalbúmina mediante sonda gástrica y medir la cantidad absorbida en sangre.
Se registraron los pesos al inicio, cambio de pienso y final de transición con los datos promedio por animal que se muestran en la Tabla 1, divididos por fase y diferenciando por machos y hembras.
El estudio comparativo muestra que el grupo prueba comenzó con un peso inicial e intermedio inferior al del control, pero al final de la transición el promedio de pesos alcanzados con el producto superó el peso de los animales control (16,40 Kg de media respecto a los 15,81 Kg del grupo control).

Analizando por sexo, hay que destacar que las hembras que consumieron el producto alcanzaron en toda la transición un mayor peso que las hembras control, independientemente del momento del pesaje (inicio, intermedio y final de transición), aunque con una mayor diferencia en la última pesada (salieron de la transición con 1,05 Kg de diferencia de media más).
En cambio, en los machos ocurrió al contrario, en todas las pesadas la media era inferior en el grupo tratado respecto al control, salvo al final de la transición.
Analizando los crecimientos en cada una de las fases se extrajeron los datos mostrados en la Tabla 2. En global se observó que se mejoraban los crecimientos a partir del momento intermedio de transición, por eso había una mejora de crecimiento del grupo prueba entre el final y el momento intermedio e inicial.

Estos datos iban asociados a una mejora de la ganancia media diaria y del índice de conversión en el grupo prueba respecto al control como se muestra en la Tabla 3.
Respecto a las bajas, se observó un porcentaje mayor en el grupo prueba (3,6%) respecto al control (2,9 %) sin poder asociarse a ninguna causa conocida.
En el estudio de las heces, en todas las observaciones realizadas según la pauta descrita en el plan de trabajo, no se evidenció ninguna diferencia entre fases o grupos, ni en consistencia ni por la presencia de diarreas.
Se realizaron todas las necropsias previstas, sin encontrar diferencias significativas en la observación macroscópica del intestino, ni en las mediciones de vellosidades y criptas, como se observa en la Tabla 4.


Tabla 4: Longitud de vellosidades, profundidad criptas y ratio en cada grupo control y prueba
En los resultados de los análisis laboratoriales, no se observaron diferencias significativas en el estudio comparativo de los parámetros de oxidación (ROS, TBARS) ni en la ocludina, como se muestra en la Figura 1.
Figura 1: Resultados de análisis laboratorial de ROS, TBARS y ocludina.

Por último, en los resultados de cuantificación de ovoalbúmina para la valoración de la permeabilidad intestinal, a nivel estadístico se encontraron diferencias significativas en los resultados (p=0,0018) sin que se demostrara presencia de ovoalbúmina en ninguna de las muestras del grupo prueba como se muestra en la Figura 2.
Los animales que han sido alimentados con el producto Vitanox han mostrado mejoras notables en su desempeño productivo, particularmente en lo que respecta a los valores de crecimiento. Este efecto ha sido más evidente en las hembras, quienes han alcanzado tasas de crecimiento superiores en comparación con los grupos control.
Dichas mejoras se han visto reflejadas en una mayor ganancia media diaria de peso, lo que indica una utilización más eficiente de los nutrientes ingeridos. Además, se ha observado una disminución en el índice de conversión alimenticia, lo que significa que los animales requieren menos cantidad de alimento para lograr un mayor peso corporal, traduciéndose esto en una producción más eficiente y rentable.
Control Prueba
Figura 2: Estudio estadístico de la ovoalbúmina como marcador de la permeabilidad intestinal.
Por otro lado, el uso del producto también ha demostrado beneficios importantes a nivel intestinal y del sistema inmunitario. Los animales que han consumido el producto Vitanox han evidenciado una reducción en la permeabilidad intestinal, lo que impide el paso de patógenos y toxinas desde el intestino hacia el torrente sanguíneo.
Como resultado, se reduce el riesgo de infecciones y problemas digestivos, lo que contribuye a un mejor estado de salud general de la explotación.
Efecto de Vitanox en la mejora de los parámetros productivos y estado sanitario del lechón en transición DESCÁRGALO EN PDF


Dr. Yron Manaig, Responsable de I+D, Animine

El destete sigue siendo uno de los momentos más críticos en la producción porcina, especialmente en regiones como Norteamérica y Asia, donde presenta importantes desafíos debido a la inmadurez en el tracto gastrointestinal.
Factores como la transición de la dieta líquida a la sólida, la baja secreción de ácido clorhídrico, la insuficiente fermentación láctica y los patrones de alimentación irregulares contribuyen a un mayor estrés por destete, niveles elevados de pH gástrico y mayor susceptibilidad a problemas digestivos.

Esta inmadurez dificulta la capacidad de los lechones para mantener un medio gástrico ácido, necesario para una actividad óptima de la pepsina (pH 2,0-3,5). Como consecuencia, se producen problemas de indigestión proteica, diarreas y proliferación de patógenos en el tracto digestivo.
Una alternativa para abordar estos retos es la inclusión de antibióticos o niveles farmacológicos de óxido de zinc (ZnO) en las dietas de transición. Esta práctica es bien conocida por reducir la diarrea postdestete y mejorar el crecimiento, la salud intestinal y la microbiota.

Sin embargo, el uso frecuente de antibióticos para controlar la diarrea genera preocupación por el desarrollo de resistencias antimicrobianas en patógenos porcinos. Esta estrategia no resuelve las causas subyacentes de la diarrea y, además, favorece la aparición de cepas resistentes, lo que supone una amenaza tanto para la salud animal como para la humana.
Por otro lado, el uso de altos niveles de Zn incrementa la excreción mineral al medio ambiente, agravando los problemas de sostenibilidad.
Otra alternativa para contrarrestar la inmadurez del estómago del lechón es ajustar su acidez mediante el uso de ingredientes con baja capacidad de unión de ácidos. Esto ayuda a mantener un pH ácido, mejorando el rendimiento en el destete.
Un aspecto clave en la formulación de dietas para lechones es comprender el concepto de Capacidad de Unión de Ácidos a pH 4 (ABC-4). La ABC cuantifica la cantidad de ácido necesaria para modificar el pH de un kilogramo de materia prima o pienso hasta un nivel determinado.

Se mide habitualmente mediante titulación en laboratorio y se expresa en miliequivalentes de ácido clorhídrico por kilogramo (mEq HCl/kg). Un nivel adecuado de ABC, especialmente a pH 4, resulta fundamental en dietas de transición. Mantener un pH inferior a 4 también contribuye a inhibir el crecimiento de microorganismos nocivos en el tracto gastrointestinal.
Por lo tanto, ajustar la ABC-4 de las dietas representa no solo una medida nutricional, sino también una estrategia sanitaria y medioambiental.

Bicarbonato sódico

Carbonato cálcico (piedra caliza) Óxido de zinc
1. Valores de ABC-4 de algunos ingredientes comúnmente utilizados en la alimentación (Lawlor et al., 2005).
Los ingredientes con un alto ABC (Fig. 1) pueden absorber grandes cantidades de ácido gástrico, dificultando que el estómago mantenga un pH óptimo de 4 o inferior.
El valor de ABC de las materias primas se correlaciona con su contenido en proteínas y minerales; así, los ingredientes ricos en proteínas (harina de colza, harina de soja, harina de pescado) y minerales (calcio, sodio, zinc) presentan valores de ABC elevados. En cambio, los ácidos orgánicos poseen valores negativos de unión de ácidos, lo que permite contrarrestar los efectos adversos de ingredientes con alta ABC.
No obstante, la inclusión de niveles farmacológicos de ZnO o de fuentes de calcio puede elevar significativamente la capacidad de unión de ácidos de la dieta, dado que el ZnO presenta uno de los valores más altos de ABC-4 (16.321 mEq HCl/kg) entre los ingredientes utilizados en alimentación animal.

La gestión del ABC-4 del pienso está siendo evaluada como alternativa a la sustitución de ZnO en niveles farmacológicos. Varios estudios realizados por la Kansas State University (KSU) han demostrado que los valores ideales de ABC-4 para lechones recién destetados oscilan entre 200 y 300 mEq HCl/kg, en función de la edad (Tabla 1).
Este ajuste se plantea como una estrategia viable para reemplazar dietas con altos niveles de ZnO sin comprometer el rendimiento productivo (Stas et al., 2022).
Valores de ABC-4 value (meq HCl/kg)
Fase 1 (0 a 10 días)
Fase 1 (0 a 10 días)
HiZox® (Animine, Francia), una fuente de óxido de zinc potenciado y respaldada por más de 30 publicaciones científicas internacionales, presenta propiedades fisicoquímicas únicas como densidad intermedia, gran tamaño de partícula y alta superficie específica.
Estas características le permiten ejercer un efecto antiwsis más bajas frente a las habituales de 3 a 4 kg/ton de ZnO estándar.

Tabla 1. Intervalo recomendado de valores ABC-4 para lechones post-destete.
Tratamiento (fuente de Zn)
Fase 1 (0–10 d)
/ 200
En este contexto, KSU realizó un estudio de 24 días combinando dietas con bajo ABC-4 y diferentes dosis de HiZox® (Tabla 2), con el objetivo de evaluar su impacto sobre el rendimiento productivo y la consistencia fecal de los lechones, como alternativa al uso farmacológico de ZnO.
*Fuentes de zinc: ZnO estándar, HiZox® (Animine, Francia)
Tabla 2. Fuentes de zinc ra diferentes dosis y sus valores correspondientes de ABC-4.*
Fase 2 (11–24 d)

El aumento de la dosis de HiZox® incrementó de manera cuadrática la ganancia media diaria (GMD) y el consumo medio diario (CMD) de pienso durante el periodo experimental, además de mejorar la eficiencia alimenticia en la fase 1. Cabe destacar que los lechones alimentados tanto con HiZox® como con ZnO en dosis farmacológicas presentaron heces firmes y consistentes, con contenidos de materia seca (MS) fecal de 26,4% y 25,5% respectivamente (Fig. 2).
La incorporación del concepto ABC-4 en la formulación de dietas para lechones, junto con el uso de una fuente de zinc potenciado como HiZox® (en dosis de 150 a 800 ppm), representa una estrategia eficaz para sustituir los altos niveles de óxido de zinc tradicionalmente empleados en la alimentación de transición.
Esta aproximación permite a los productores aprovechar un entendimiento holístico de la fisiología de la digestión proteica y la modulación del pH, optimizando así el potencial genético de los animales, al tiempo que se ajusta a las normativas vigentes, las exigencias medioambientales y las demandas del mercado
Estos resultados indican que una dosis baja de óxido de zinc potenciado (HiZox®) puede contribuir a reducir o alcanzar un valor óptimo de ABC-4 en la dieta (200 mEq HCl/kg), mostrando resultados comparables a los obtenidos con ZnO farmacológico en términos de ingesta, crecimiento, eficiencia alimenticia y control de diarrea.
DESCÁRGALO EN PDF
Figura 2. Rendimiento productivo y características fecales de los lechones destetados a los 24 días (P < 0,05).




MANGANESO

MANGANESO




Equipo técnico Biocidas ZIX

En la producción porcina moderna, mantener la eficiencia digestiva y la salud intestinal es fundamental para la rentabilidad. Uno de los principales desafíos es la presencia de agentes bacterianos oportunistas, en especial
Clostridium perfringens.

Aunque tradicionalmente se ha asociado con la mortalidad temprana en lechones lactantes, investigaciones recientes indican que este patógeno puede afectar a los cerdos durante todas las fases de producción —desde el nacimiento hasta el engorde— tanto en formas clínicas como subclínicas.

Comprender cómo actúa C. perfringens en cada etapa del ciclo productivo y conocer los factores que favorecen su proliferación es esencial. Abordar este problema requiere estrategias modernas que vayan más allá del uso clásico de antibióticos, para lograr un control efectivo y mejorar la salud del lote.

Clostridium perfringens es una bacteria anaerobia estricta, formadora de esporas, que produce varias toxinas altamente activas que afectan principalmente al intestino.

Esta bacteria está ampliamente distribuida en el ambiente y forma parte de la microbiota intestinal normal en animales sanos.
Sin embargo, bajo ciertas condiciones, puede multiplicarse descontroladamente y volverse patógena.
Se clasifica en los tipos A, B, C, D y E según las toxinas que produce. En porcino, los tipos A y C son los más relevantes.
El tipo A produce toxina alfa y a veces toxina beta-2. Está presente en animales sanos, pero puede causar enfermedades entéricas crónicas o subclínicas.
Durante los primeros días de vida, el sistema digestivo del lechón es aún inmaduro, lo que lo hace vulnerable a la colonización rápida por Clostridium perfringens tipo C.
Esta bacteria libera toxinas que pueden provocar síntomas graves como diarrea hemorrágica, espesa y de olor fétido, letargo, deshidratación e incluso muerte súbita.
Si no se trata a tiempo, la tasa de mortalidad puede ser muy alta.
La transmisión suele producirse por contacto con superficies contaminadas (suelos, piel, ubres) o a través de esporas presentes en la cama, el agua o el ambiente. Las cerdas portadoras asintomáticas también pueden ser fuente de infección.
El diagnóstico generalmente se confirma mediante necropsia, donde se observan mucosa intestinal necrótica y hemorragias, además de detección de toxinas en el contenido intestinal. No obstante, el aislamiento bacteriano por sí solo no siempre es concluyente.
Las medidas preventivas son fundamentales e incluyen la vacunación de las cerdas gestantes contra Clostridium perfringens tipo C en el último tercio de gestación. También es crucial la limpieza, desinfección y secado riguroso de las cerdas antes del parto, con especial atención a las ubres.
Además, es esencial desinfectar continuamente el agua para evitar la formación de biofilm, ya que puede actuar como reservorio de bacterias.
El destete es un período crítico para los lechones. En esta etapa dejan de recibir leche materna, cambian de dieta, pierden la inmunidad pasiva y enfrentan estrés ambiental. Estas condiciones favorecen la proliferación de Clostridium perfringens tipo A.

Este patógeno suele causar diarreas blandas o acuosas sin sangre, pérdida de apetito, retraso en el crecimiento y alta morbilidad con baja mortalidad.
También puede tener efectos subclínicos que afectan la eficiencia alimentaria.
Las toxinas que produce dañan la mucosa intestinal, aumentan la permeabilidad epitelial y reducen la absorción de nutrientes, lo que puede derivar en una enteritis necrótica.
La fase de engorde es una etapa vital, pero a menudo subestimada, especialmente en lo que respecta a la fermentación intestinal y su impacto sobre la eficiencia alimentaria.
En esta etapa, los cerdos han alcanzado un peso considerable y su sistema digestivo está completamente desarrollado.
La fermentación que ocurre en el intestino grueso, especialmente en el ciego y el colon, es clave para convertir los residuos alimenticios no digeridos en ácidos grasos volátiles como acetato, propionato y butirato.
Diagnosticar esta condición es un reto, ya que el patógeno forma parte de la flora normal. La confirmación requiere análisis de toxinas en el contenido intestinal, hisopos rectales o estudios histopatológicos para identificar lesiones específicas.
Para prevenir problemas relacionados con el tipo A, es importante controlar el estrés del destete, mantener una limpieza rigurosa entre lotes, desinfectar los sistemas de agua, eliminar el biofilm y diseñar adecuadamente la dieta con fibras fermentables y proteínas digestibles.

Estos ácidos no solo son una fuente importante de energía, sino que también apoyan la salud intestinal, la regulación del metabolismo y la función inmune.
Sin embargo, un sobrecrecimiento de Clostridium perfringens puede alterar este equilibrio, provocando fermentaciones patológicas.
Esto genera gases y metabolitos tóxicos que irritan la mucosa intestinal, causan inflamación y reducen la absorción de nutrientes.


Las consecuencias incluyen una menor eficiencia alimentaria, crecimiento más lento, variabilidad en el peso y aumento de los costes de producción.
Factores como dietas ricas en proteína no digerida, mala gestión del agua, estrés, limpieza insuficiente o un uso inadecuado de antibióticos pueden favorecer la proliferación de esta bacteria.
Comprender estas dinámicas permite gestionar mejor esta fase, optimizando la conversión alimenticia y la salud del lote.


Clostridium perfringens sigue siendo un desafío persistente en todas las etapas de la producción porcina, especialmente durante el engorde. Es esencial implementar algunas medidas clave para mantener la salud del animal:
AUMENTAR LA FIBRA FERMENTABLE
Estimula la flora intestinal beneficiosa y favorece la producción de ácidos grasos volátiles (AGVs), esenciales para la salud intestinal.
Evita el exceso de sustrato disponible para bacterias patógenas como Clostridium spp., reduciendo el riesgo de fermentaciones indeseadas.
Fundamental para romper el ciclo de infección y reducir la carga microbiana en el entorno.

Para una limpieza adecuada, se debe usar un detergente alcalino para eliminar la materia orgánica que protege a los patógenos en las granjas. Se recomienda el uso del detergente espumante Clean Zix para una limpieza y desincrustación adecuada.
Una vez limpia, se debe desinfectar con productos de amplio espectro y biodegradables. Se recomiendan los desinfectantes Virox y Zix Virox , los cuales actúan por oxidación.
DE LA CALIDAD MICROBIOLÓGICA DEL AGUA Y ELIMINACIÓN DEL BIOFILM EN LÍNEAS DE AGUA
El agua es un vector crítico. La higiene del sistema evita la formación de reservorios bacterianos.

Para evitar los problemas asociados a una mala calidad microbiológica del agua, como para prevenir el biofilm, recomendamos el uso de Aquazix ®
Plus Ag de forma continua, ya que de esta manera se conseguirá un agua de gran calidad microbiológica y la eliminación de biofilm.
Proporcionar agua de calidad a nuestros animales reducirá el riesgo de ingestión de patógenos y ayudará a prevenir enfermedades.
El manejo debe garantizar condiciones estables para minimizar factores que favorezcan disbiosis intestinal.
Abordar el desafío de Clostridium perfringens con un enfoque basado en nutrición estratégica, bioseguridad y control ambiental.
Si tienes preguntas o deseas hablar sobre cómo implementar estas estrategias en tu explotación, no dudes en contactarnos.
Clostridium perfringens en porcino: impacto en las distintas fases de producción y estrategias clave de control DESCÁRGALO EN PDF



Sinrecetaveterinaria


• Favorece el equilibrio de la microbiota intestinal
• Mantiene la sanidad del sistema digestivo
• Mejora la fisiología digestiva
• Mejora los parámetros productivos
• Disminuye el uso de antibióticos
• Valores de matriz consolidados a través de pruebas experimentales

• Resultados óptimos en presencia de sustratos diferentes, gracias a la respuesta digestiva de los probióticos
• Mejora de la salud del tracto digestivo al reforzar la pared intestinal y la producción de ácidos grasos de cadena corta
• Rentabilidad sostenible junto a un ahorro en los costes de alimentación

Rafael Durán Giménez-Rico 1 y Félix Calvo Falcón 2
1 Regional Technical Manager, IFF Danisco Animal Nutrition & Health
2 Business Manager, IFF Danisco Animal Nutrition & Health

Incluso en el caso de las mejores prácticas de manejo, la eficiencia digestiva de los cerdos está muy por debajo de lo deseable y se estimaba, ya hace décadas en trabajos exhaustivos de Noblet, entre 78%-82%.
Es decir, el potencial de un pienso desde el contenido en energía bruta (EB), se reduce desde su ingesta y hasta la producción de heces, entre un 20-22%; desde ese momento de la fisiología digestiva, el alimento aporta energía digestible (ED).
Dado que el alimento representa el mayor gasto en la producción de carne de cerdo, este primer paso tan ineficaz, representaría un aspecto a considerar y a tener en cuenta desde el punto de vista de “manejo digestivo”.
Tomando este momento como un punto en el que, desde IFF Danisco Animal Nutrition & Health, se aborda como un reto, queremos compartir esta información, resultado de años de desarrollo de un nuevo producto.
En los mercados en los que nos movemos, observamos desde hace años, que en la fabricación de piensos la incorporación/utilización de otras materias primas que antes no se consideraban es un hecho.
El uso de ingredientes alternativos de menor coste, tanto derivados de cereales – coproductos – como otras fuentes de proteína vegetal es ya una realidad.
Éstas y aquellas, al incorporarse en la mezcla, consiguen que el coste por tonelada del pienso compuesto disminuya sensiblemente.
También es cierto que nos enfrentamos generalmente a dietas potencialmente menos digestibles – es decir que ese 78-82% puede verse disminuido – dado el mayor aporte de fibra dietética, que entre otras fracciones incluye los polisacáridos no amiláceos (PNA).
Estos ingredientes más económicos suelen ser de menor calidad digestiva, con un contenido nutricional inferior como ya se ha dicho.
Además de un mayor contenido fibroso, ciertos ingredientes contienen, además, factores antinutricionales, que van a afectar no solo la capacidad digestiva de los animales, sino la absorción del resto de nutrientes de la dieta.
En consecuencia, y debido a una mayor proporción de sustratos alimenticios sin digerir correctamente, pasando al intestino grueso –pero incluso dentro del delgado – se produce una alteración de la flora microbiana.
Y como efecto directamente ligado a esto:
Una posible inflamación intestinal.
Daños en la mucosa intestinal – pectinas-.
Fermentaciones nocivas.
Mayor excreción de heces.
Producción de amoníaco por descomposición de la urea en orina y proteínas no digeridas.
Si nutrientes no digeridos, como estos, llegan al intestino grueso, se produce un aumento en la producción de amoníaco y un desequilibrio de la microflora a favor de bacterias no beneficiosas o incluso oportunistas/patógenas. Esto afecta negativamente la digestibilidad, la función inmunitaria y el rendimiento.


El aumento de la fibra dietética en los piensos al utilizar ingredientes con mayor contenido en ésta puede provocar además lo que denominaríamos “efecto jaula”.
Este efecto tiene lugar cuando la fibra de naturaleza más insoluble – arabinoxilanos, celulosa, etc- encierra literalmente a otros nutrientes de adecuada digestibilidad por sí mismos, pero que resultan menos accesibles para las enzimas de naturaleza endógena.
Siendo este el caso, existe una necesidad de empleo de enzimas exógenas – añadidas al pienso a través de premezclas o de forma líquida- de naturaleza carbohidrasa.
El efecto que se busca es el de unirse a los distintos sustratos de forma eficaz, para descomponerlos en moléculas de menor tamaño, quebrándose así las estructuras más complejas, que permitan el acceso de actividades endógenas – amilasa pancreática, peptidasas, tripsina, quimotripsina, etc-, mejorando la digestibilidad de ese alimento.

Las enzimas exógenas se emplean en la industria porcina desde los años 90 y, con mayor o menos éxito en las distintas zonas del mundo, son aditivos ampliamente aceptados y utilizados, bien es cierto que más en lechones y cerdos en crecimiento, que en engorde-fina -
La fitasa, por ejemplo, debido a su enorme desarrollo técnico, su eficacia frente al fitato es muy superior ahora, logrando que una serie de nutrientes sean más disponibles, lo que da lugar a matrices nutricionales muy sólidas.
La penetración de fitasas en el mercado global de enzimas exógenas alcanza el 90%, su uso específico en porcicultura aún no es universal, pero está en crecimiento constante debido a los beneficios demostrados en digestibilidad, ahorro de fósforo inorgánico y reducción del impacto ambiental.
Pero volviendo la vista al párrafo del desafío, los PNA suponen un desafío digestivo incluso para cerdos en engorde y finalización; siempre existirá la posibilidad de cierta mejora en la digestibilidad de dicha fracción, incluso en el caso de cerdas lactantes, como tantas veces hemos demostrado en pruebas científicas (ver Figura 1 abajo).
Energía Digestible, kcal/kg pienso
+100 g/t
Digestibilidad de Polisacáridos no amiláceos, %
Control
+100 g/t
Digestibilidad celulosa, %
Control
+100 g/t
Digestibilidad hemicelulosa, %
Control
+100 g/t
(a,b): valores con superíndice diferente son diferentes significativamente (P<0.05)
Figura 1. Mejoras de la digestibilidad en cerdas lactantes alimentadas con Xilanasa/Betaglucanasa (1.220 U/kg y 152 U/kg) 17 días antes del parto y durante la lactación de 28 días.
El uso de probióticos tan extendido en avicultura, también tiene un porcentaje de utilización importante en ganado porcino.
Desde la total erradicación del uso del óxido de Zn en lechones (2022), añadido a esto el progreso en la eliminación del uso de antibióticos como promotores de crecimiento, que comenzó en los años 90 y se plasmó en su prohibición en enero de 2006, en la producción porcina han encontrado hueco distintos aditivos encaminados a mejorar los rendimientos; junto a las mencionadas enzimas exógenas, destacar los probióticos.
Estos han demostrado un impacto positivo en el crecimiento y en la salud animal; desde hace muchos años, antes de la fecha mencionada, los probióticos se utilizaban con éxito en cerdas lactantes. Es decir, no era un aditivo “desconocido”.
De cualquier forma, y debido a un mecanismo de acción absolutamente diferente al de los antibióticos, es una herramienta que ha pasado por muchas épocas, de mayor y menor utilización.
Debido precisamente a un “reconocimiento” no siempre consolidado, sobre todo en fases de cerdos más adultos, dentro de nuestro departamento de Innovación y Desarrollo de ideas/productos, concluimos que:
Una combinación muy cuidada, ciertamente bien desarrollada con experiencias, primero de nivel laboratorial, pero más adelante, con multitud de experiencias “in vivo”, era lo más adecuado para mejorar los rendimientos en ganado porcino en toda la fase de crecimiento y cebo.



Syncra SWI, que así se llama lo que nosotros denominamos Solución -herramienta única-, es la combinación cuidadosamente diseñada de tres cepas de Bacillus y una enzima de actividad proteasa.
Esta combinación ha demostrado resultados positivos de forma consistente; mejoras en la digestibilidad de los aminoácidos, un aumento de la viabilidad de los animales tratados y mejoras en el crecimiento en los diferentes periodos probados.
Además de las mencionadas pruebas in vivo, se realizaron trabajos de cribado y selección de las cepas de Bacillus más eficaces en solubilización de los complejos fibra-proteínas en los distintos ingredientes estudiados en el interior del intestino delgado de cerdos en crecimiento.
Además, una combinación de 6 pruebas con el mismo diseño experimental, arrojó mejoras significativas de 3% y 4% en crecimiento e índice de conversión respectivamente (Figura 2).
En otras 5 pruebas comerciales a gran escala, controlando de forma eficaz más de 5.000 cerdos, se observó un aumento del 2% de la viabilidad de los animales.
La combinación de los 3 probióticos y la proteasa dan como resultado una sinergia que se traduce en una acción combinada entre las enzimas producidas “in situ” junto a la proteasa exógena añadida.
Las cepas de Bacillus están en forma de esporas, resistentes a altas temperaturas, así como al pH estomacal ácido; en el intestino esas esporas germinarán y serán capaces de producir las enzimas más necesarias para digerir el sustrato presente.

Esta forma de “añadir” enzimas es muy ventajosa: no existe el riesgo de que un exceso de temperatura, un pH excesivamente ácido o incluso el efecto de la pepsina, puedan inactivarla y no ejercer el papel para el que está diseñado el producto.
Crecimiento medio diario (g/cerdo/día, 25-114 kg)
(25-114 kg)

Control Control + Combinación de probiótico y proteasa* (a,b): valores con superíndice diferente son diferentes significativamente (P<0,05)
Figura 2. Resultados de 6 pruebas combinadas en crecimiento y cebo (25-114 kg) con la utilización de la combinación Probiótico (Bacillus)-proteasa.
Mejora de la digestibilidad ileal de los aminoácidos esenciales (Figura 3) y la energía, que redunda en mejores crecimientos, reforzando además la capacidad del sistema inmunitario en general.
Resultados consistentes con dietas muy variadas, debido a la capacidad de adaptación del producto a sustratos de muy diferente naturaleza fibrosa.
Debido a una mejor digestión y absorción de la proteína y aminoácidos, se produce una reducción significativa de las fermentaciones proteicas, disminuyendo significativamente la emisión amoníaco, asociado además a una reducción de flora patógena.

Efecto modulador de la flora microbiana, hacia bacterias productoras de ácidos grasos beneficiosos; aumento de los Lactobacillus
Una mayor y más eficaz producción de ácidos grasos de cadena corta (Figura 4), con efectos positivos asociados; pH ácidoreductor de patógenos- y fuente de energía para los enterocitos.
Mejoras cercanas al 2% en la viabilidad de los animales tratados, con el beneficio económico que esto comporta.

Aminoácidos digestibles ileales (g/100 g de alimento)
Bacillus & Proteasa Control
(a,b): valores con superíndice diferente son diferentes significativamente (P<0,05)


Figura 3. La combinación Probiótico (Bacillus)-Proteasa aumenta significativamente la digestibilidad ileal de aminoácidos esenciales, reduciendo la necesidad de su utilización sintética.
Ácidos grasos totales (mM, 18 horas)
Ácido butírico (mM, 18 horas)
(*, **): valores con asteriscos tienden a ser diferentes significativamente (*P=0,13< ** P=0,16)
Figura 4. La combinación Probiótico (Bacillus)-Proteasa aumenta la producción de ácidos grasos de cadena corta debido a una menor presencia de proteína en el intestino grueso.
Mejorar la eficiencia alimenticia mediante una herramienta única DESCÁRGALO EN PDF
Dr. Behnam Saremi

Head of technical marketing department, CJ Europe GmbH, Frankfurt am Main, Germany
Traducción y adaptación: Dpto. Técnico de Alimentación Animal, Quimidroga SA.

Tradicionalmente, en nutrición porcina la arginina se ha considerado un aminoácido semi-esencial. Esto quiere decir que, aunque el animal es capaz de existen situaciones
determinadas en que su aporte a través de la dieta (NRC, 2012).



Recientemente, el avance genético de las razas modernas de alta productividad nos lleva a cuestionarnos si esta síntesis endógena de arginina es suficiente para satisfacer los requerimientos en las distintas fases productivas y procesos fisiológicos relacionados con el crecimiento, la eficiencia reproductiva y la supervivencia embriofetal.
Muchas de las tablas de requerimientos nutricionales, incluyendo las de FEDNA, resultan limitadas en cuanto a las recomendaciones de arginina. Únicamente guías más recientes, como las de Brasil, contemplan niveles adecuados para responder a las exigencias productivas de las líneas genéticas actuales.

Las cerdas reproductoras modernas, fruto de la selección genética, presentan una elevada prolificidad. En el caso de las líneas hiperprolíficas, que pueden alcanzar camadas de hasta 20 fetos vivos, la correcta implantación y placentación embrionaria son claves para asegurar la supervivencia fetal hasta el parto (Elmetwally et al., 2022).
El crecimiento de los fetos depende en gran medida del desarrollo y la vascularización de la placenta, ya que un tamaño adecuado facilitará el intercambio de nutrientes cerda-embrión.
Tabla 1. Recomendaciones nutricionales de arginina en cerdos.
La arginina actúa como precursor de distintos metabolitos, como las poliaminas y el óxido nítrico (ON), los cuales intervienen en la regulación de la presión arterial y la angiogénesis, contribuyendo al desarrollo placentario y a la supervivencia de los lechones.
Diversos estudios han demostrado que aumentar las ratios de Arg:Lys SID durante la gestación, puede mejorar los parámetros reproductivos, incrementando el tamaño y vascularización de la placenta, el número de lechones nacidos vivos y su peso al nacimiento (Virdis et al., 2023; Wu et al., 2018).
La arginina, como precursora del ON, también desempeña un papel importante en la regulación del flujo sanguíneo hacia la glándula mamaria. La producción de ON facilita la vasodilatación, lo que incrementa el aporte de nutrientes y oxígeno a las células epiteliales mamarias, promoviendo tanto la síntesis de proteínas como la disponibilidad de nutrientes para la leche.
Además, la arginina puede influenciar la secreción de prolactina, hormona que estimula el desarrollo mamario y la producción de leche. Esto sugiere que el aumento del ratio de Arg:Lys SID podría promover un aumento de peso en los lechones al final de la fase de lactación (Cruz et al., 2025).
La prohibición del uso de dosis farmacológicas de óxido de zinc (ZnO), junto con la restricción del uso profiláctico de antibióticos, han favorecido un incremento en la incidencia de diarreas post-destete. Como respuesta sistemática, muchos países europeos han optado por formular las dietas post-detete con un contenido bajo en proteína, en torno al 15-16%.
Para poder formular con niveles tan bajos de proteína, ha resultado clave la disponibilidad de aminoácidos cristalinos, como la isoleucina y la histidina, para evitar la reducción en el crecimiento de los lechones. En este contexto, la arginina es fundamental para mejorar la salud intestinal y la respuesta inmune de los animales, garantizando así el rendimiento productivo.
Un estudio reciente realizado por la universidad de Berlín en cerdas en fase de lactación ha demostrado que aumentar la ratio de Arg:Lys SID del 79% al 110% incrementa en 1,5 kg el peso al destete de los lechones, mostrando un efecto sobre el peso vivo que se prolonga hasta 14 días post-destete (datos no publicados).
En dos nuevos ensayos dosis-respuesta realizados por CJ BIO en Estados Unidos (PerezPalencia et al., 2024), han evaluado diferentes ratios de Arg:Lys SID en lechones durante las primeras tres semanas post-destete.
En el primer estudio se formularon cinco dietas bajas en proteína (16,31% PB) y soja, y altas en lactosa, aplicando niveles crecientes de Arg:Lys (de 44% hasta 116%). Tras tres semanas de tratamiento, todos los animales fueron alimentados con una dieta única (83% Arg:Lys) hasta las seis semanas post-destete. Los animales se siguieron hasta el sacrificio.
Los resultados indicaron que el nivel óptimo de Arg:Lys SID para maximizar el rendimiento productivo se sitúa en una ratio de entre 90% y 100%, dependiendo del parámetro a evaluar (peso corporal o índice de conversión a los 21 días post-destete).
En el segundo estudio, partiendo de una dieta alta en proteína (20,9% PB) y soja, se incrementó la ratio de Arg:Lys de 74% a 136% durante la primera semana postdestete, y de 87% a 150% las dos semanas posteriores. Hasta las 6 semanas post-destete los lechones se alimentaron con una dieta única (83% Arg:Lys SID) y se siguieron hasta el sacrificio como en el estudio anterior.
En este caso, el nivel óptimo de Arg:Lys SID se situó entre 120-130%, dependiendo del parámetro evaluado (peso corporal o conversión alimenticia a los 21 días post-destete).

Peso a los 21 días
La conclusión de estos estudios es que la ratio de Arg:Lys es más elevada en las dietas con alto contenido en proteína bruta que en dietas con una proteína bruta más baja. A su vez, en ambos casos, las ratio Arg:Lys SID son superiores a los niveles recomendados actualmente para lechones en esta fase productiva (Figura 1).

Experimento I Experimento II
Niveles de Arginina SID, % de la dieta
Niveles de Arginina SID, % de la dieta
Experimento I Experimento II
GDM durante los 21 días post destete
GDM desde el destete hasta el peso comercial
Niveles de Arginina SID, % de la dieta
Experimento I
Experimento II
Niveles de Arginina SID, % de la dieta
Experimento I Experimento II
Figura 1. Niveles de Arginina SID óptimos para cerdos destetados según el rendimiento del crecimiento durante las tres primeras semanas post-destete y la GMD hasta el peso de sacrificio. Los lechones al destete requieren entre un 1,38 % y un 1,93 % de arginina SID para un rendimiento óptimo del crecimiento durante las primeras semanas tras el destete y la GMD hasta el peso de comercialización (Adaptado de Pérez-Palencia et al. 2024).

Humphrey et al.(2024) realizaron otro estudio dosis-respuesta en lechones al destete, utilizando genética PIC y lechones de 6-13 kg de peso vivo durante un periodo de 41 días. Durante los primeros 27 días, con 2 fases de alimentación, se evaluaron 6 tratamientos con distintas ratios de Arg:Lys SID (desde 45% a 145%). Posteriormente, los animales se alimentaron con una dieta comercial común hasta el final del ensayo.
Período de dieta experimental (día 0 al 27)
Peso corporal al día
Período de dieta común (día 27 al 41)
El peso corporal y el consumo de pienso óptimos se obtuvieron con ratios de Arg:Lys SID de entre el 96 % y el 101 % (Tabla 2).
Todo el período (día 0 al 41)
¹Máximo calculado de la curva de regresión cuadrática. El máximo de la curva se calculó cuando el coeficiente cuadrático P ≤ 0.1.
En conclusión, en base a estudios realizados recientemente con genéticas de alta producción, el nivel óptimo de Arg:Lys SID para maximizar los rendimientos productivos en diferentes fases se sitúan en torno al 105% en lechones y al 125% en cerdas.
Las dietas actuales bajas en proteína, junto con el avance genético de los animales, hacen recomendable para la industria porcina la revisión y actualización de los requerimientos nutricionales de este aminoácido.
Tabla 2. Modelo de regresión cuadrática ajustado a diferentes parámetros en respuesta al aumento de Arg: Lys SID en lechones de transición (adaptado de Humphrey et al., 2024).
¿Es la arginina un nuevo aminoácido esencial en porcino? DESCÁRGALO EN PDF
Precursora natural del óxido nítrico, la L-Arginina mejora el crecimiento y la reproducción de los animales

Dr. Christof Rapp
Nutricionista porcino, Zinpro Corporation

El destete es un periodo crítico y que conlleva un estrés significativo para los lechones, donde son especialmente vulnerables a los patógenos. Una nutrición específica con zinc y hierro durante esta fase puede mejorar su estado sanitario y crecimiento.
El zinc es vital para los lechones destetados: mantiene a la barrera intestinal impermeable, lo que evita que las toxinas y los patógenos la atraviesen, previniendo que alcancen los tejidos y provoquen inflamación.
Si los patógenos atraviesan la barrera intestinal, es esencial que la respuesta inmunitaria sea rápida. La velocidad de la respuesta depende de la replicación de las células inmunitarias, lo que también requiere zinc.

En un estudio realizado con lechones de 7 semanas de edad infectados con Lawsonia intracellularis (ileítis), se observó una recuperación más rápida en los lechones que recibieron Zinpro Availa Zn (Figura 1) como sustituto de parte del zinc inorgánico.
El zinc puede ser suplementado en forma inorgánica u orgánica (quelada), aunque no todas las fuentes orgánicas son iguales:
el zinc presente en Zinpro® Availa® Zn está unido a una sola unidad de aminoácidos y utiliza transportadores de aminoácidos para una absorción única.
Este complejo de zinc y aminoácido único no es degradado en el estómago, lo que aumenta la disponibilidad metabólica del zinc.
Estos lechones mostraron:
Menos daño intestinal Mayor número de células inmunitarias También se observó un mayor número de lechones con anticuerpos.
Esto demuestra que la suplementación con Zinpro Availa Zn mejora la integridad intestinal y acelera la recuperación de los animales en caso de ileítis.

Figura 1. Puntuación de lesiones intestinales en lechones destetados 28 días después de la exposición a Lawsonia intracellularis (ileítis), Leite et al., 2018.
El hierro es esencial para el transporte de oxígeno, el metabolismo energético y el correcto funcionamiento del sistema inmunitario.
Si bien la prevención de la anemia en lechones lactantes y destetados es una preocupación primordial, el hierro también desempeña un papel fundamental en la salud intestinal.
En el intestino, el huésped y los microbios (incluidos los patógenos) compiten por el hierro.
El exceso de hierro puede favorecer el crecimiento de patógenos y actuar como prooxidante, aumentando el estrés oxidativo y la inflamación, debilitando la barrera intestinal.
Los piensos de destete contienen al menos 100-200 ppm de hierro procedente de ingredientes como la harina de soja, el salvado de trigo, el fosfato y el carbonato cálcico.
La inclusión de fitasas libera parte de este hierro, aumentando su disponibilidad, tanto para los cerdos como para los microbios.

Además, entre 100 y 150 ppm de hierro suele ser añadido de forma adicional, lo que eleva los niveles totales a entre 200 y 350 ppm.
Sin embargo los lechones recién destetados no absorben bien el hierro procedente de los piensos o de fuentes inorgánicas.
Para reducir el estrés oxidativo, se puede aportar el hierro con una fuente no oxidante y con alta disponibilidad metabólica como Zinpro® ProPath® Fe, donde el hierro presente está unido a una sola unidad de aminoácido.
Esto permite reducir el nivel de inclusión de hierro añadido a la vez que se asegura que las necesidades de los lechones estén cubiertas.

Un estudio realizado en la Universidad Estatal de Iowa demostró que los lechones alimentados con un pienso suplementado con 100 o 50 ppm de Zinpro ProPath Fe presentaron una mortalidad menor que los alimentados con un pienso con 100 ppm de hierro en forma de FeSO 4.

Sin embargo, la inclusión de 25 ppm de Zinpro ProPath Fe resultó insuficiente, lo que indica que, aunque pueda reducir de forma significativa la mortalidad, una dosis demasiado baja puede comprometer la supervivencia (Figura 2).
El zinc y el hierro juntos tienen un efecto positivo en el crecimiento de los lechones.
Un estudio danés comparó dos estrategias de suplementación post destete en 757 lechones (con un peso medio de 6,6 kg).
Un grupo recibió la dieta estándar de la granja (control), mientras que el otro grupo recibió una dieta donde se sustituyó 50 ppm de zinc y 90-45 ppm de hierro inorgánicos por la misma cantidad de Zinpro Availa Zn y Zinpro ProPath Fe desde el día 1 al 28.
El hierro suplementario total osciló entre 190 y 220 ppm en la dieta de control y fue de 140 ppm en la dieta Zinpro ProPath Fe. Del día 29 al 42, solo se incluyó con Zinpro Availa Zn.

El estado de salud fue bueno en general, sin diferencias en cuanto a diarrea o días de medicación.
Sin embargo, la mortalidad se redujo a la mitad en el grupo Zinpro Availa Zn y Zinpro ProPath Fe (0,8 % frente a 1,6 %), lo que confirma los hallazgos anteriores sobre el impacto positivo del zinc y el hierro aportado en forma de Zinpro® Performance Minerals®.
Cabe destacar que los lechones alimentados con Zinpro ProPath Fe y Zinpro Availa Zn presentaron un crecimiento mayor:
569 g frente a 541 g de ganancia media diaria, lo que se tradujo en 1,1 kg más de peso corporal al día 42 (Figura 3).
El uso de formas metabólicamente disponibles de zinc y hierro puede fortalecer la integridad intestinal, reducir el estrés oxidativo y reforzar el sistema inmunitario.
Estas mejoras se traducen en un mejor estado sanitario, un mayor crecimiento y mejores resultados productivos.
Mejorando el estado sanitario y los resultados productivos con Zinc y Hierro en lechones destetados DESCÁRGALO EN PDF
3. Peso corporal de los lechones en el último día del estudio (día 42), fabricante de piensos, Dinamarca.



Añadir Zinpro® Availa® Zn y Zinpro® ProPath® Fe a las dietas transición puede contribuir a reducir la mortalidad.
Zinpro Availa Zn y Zinpro ProPath Fe aportan zinc y hierro metabólicamente disponibles para reforzar la integridad intestinal, reducir el estrés oxidativo y reforzar el sistema inmunitario. Esto se traduce en lechones más fuertes, con un crecimiento mayor y mejores resultados

Escanee el código QR para VER LA DIFERENCIA o póngase en contacto con Luis da Veiga en ldaveiga@zinpro.com

Dante Javier Bueno, Instituto Nacional de Tecnología Agropecuaria
EEA Concepción del Uruguay, Facultad de Ciencia y Tecnología, sede Basavilbaso, Universidad Autónoma de Entre Ríos

Las micotoxinas son metabolitos secundarios producidos por hongos filamentosos, siendo los géneros más importantes Aspergillus, Penicillium, Fusarium y Aternaria. Estas toxinas están presentes en diversos cultivos, tienen un fuerte impacto en la calidad y la seguridad de los alimentos y piensos en todo el mundo.


Entre las micotoxinas de importancia en las aves se destacan las aflatoxinas (siendo la B1 la más importante), las ocratoxinas (A es la más importante), los tricotecenos (en especial, deoxinivalenol-DON-, toxina T-2), la zearalenona (ZEA) y las fumonisinas (siendo la B1 la más importante).

Estas toxinas suelen estar presentes en forma simultánea con efectos sinérgicos o aditivos y, a su vez, pueden dar lugar a metabolitos de igual o mayor poder tóxico, algunos de ellos conocidos como micotoxinas enmascaradas, que causan problemas en la detección analítica por métodos convencionales (Okasha et al., 2024: Olariu et al., 2025).
Durante décadas de lucha contra el problema de las micotoxinas, se han probado muchos tratamientos: desde físicos hasta químicos y biológicos. El control de las micotoxinas se puede hacer a nivel precosecha, cosecha y postcosecha. Si bien la infestación por hongos toxicogénicos y la síntesis de micotoxinas son inevitables en ciertas circunstancias ambientales, su prevención es el objetivo principal.
Por lo tanto, las prácticas adecuadas precosecha y una buena calidad inicial de los cereales representan la primera línea de combate, aunque los sistemas de control postcosecha son esenciales para disminuir la contaminación final de diversos productos agrícolas (Zhang et al., 2024).
Cuando la planta de balanceados adquiere granos de buena calidad, el objetivo es el mantenimiento de esa calidad durante el almacenamiento y procesamiento hasta la distribución del producto. Sin embargo, cuando, por algún motivo, se adquiere grano de baja calidad, el objetivo de la planta de balanceados será minimizar los riesgos y daños a la industria animal.
Se han implementado diversos métodos para garantizar la descontaminación de productos afectados o para disminuir la exposición a micotoxinas, pero no todas las estrategias son adecuadas para diferentes propósitos.
El enfoque basado en agentes biológicos es muy prometedor en términos de eficiencia y especificidad, con un impacto positivo en el ambiente y la seguridad alimentaria. Los principales métodos biológicos están basados en el uso de agentes microbiológicos y enzimas en alimentos y piensos (Zhang et al., 2024).
Por ello, en este artículo se abordará las estrategias que pueden ser utilizadas en el control biológico de las micotoxinas, en especial, en el alimento de las aves.

La biodesintoxicación es un enfoque reciente que utiliza microorganismos no patógenos o sus enzimas, a través de procesos catabólicos, para disminuir la cantidad de micotoxinas. Estos microorganismos, además de reducir o eliminar las toxinas para convertirlas en compuestos menos nocivos o inofensivos, se consideran en general seguros, porque generan productos finales útiles a través de procesos de bioadsorción o biodegradación.
La competencia por el espacio vital y los nutrientes requeridos para el crecimiento, la función parasitaria, el metabolismo y el parasitismo de los hongos patógenos dan lugar al efecto antagónico de los probióticos sobre estos últimos (Nešic et al., 2021, Zhang et al., 2024).
Los estudios a menudo identifican erróneamente la biodegradación con la desintoxicación, o no evalúan la toxicidad de los metabolitos potenciales. De hecho, no todos los productos de transformación o degradación son productos de desintoxicación.
Por otro lado, el conjunto disponible de microorganismos degradadores de micotoxinas es limitado y su rendimiento suele ser dudoso cuando se considera la degradación de múltiples micotoxinas.
Se recomienda comparar las cepas funcionales con la lista de agentes generalmente reconocidos como seguros (GRAS) de la Administración de Alimentos y Medicamentos (del inglés Food and Drug Administration, FDA) de los Estados Unidos y la lista de Presunción Cualificada de Seguridad (del inglés Qualified Presumption of Safety, QPS) de la Autoridad Europea de Seguridad Alimentaria (del inglés European Food Safety Authority, EFSA).
Los agentes biológicos pertenecientes a la lista GRAS están exentos de la revisión previa a la comercialización y de la aprobación de la FDA. Asimismo, los agentes biológicos incluidos en la lista QPS suelen someterse a una evaluación simplificada por parte de la EFSA.

Los microorganismos que no se encuentran bien definidos, que presentan problemas de seguridad conocidos o sobre los cuales no es factible determinar si representan un riesgo para los seres humanos, la fauna o el ambiente, no son aptos para obtener el estatus de QPS y deben ser sometidos a una evaluación exhaustiva de seguridad (FDA, 2018, EFSA, 2025).

La capacidad de las bacterias para reducir el contenido de micotoxinas depende de la selección de cepas (Tabla 1). Las cepas que reducen el contenido de una micotoxina no necesariamente tienen que ser eficaces en la degradación de otro grupo de micotoxinas.
Así también, la concentración bacteriana y de micotoxinas, la temperatura, el pH, el tiempo de incubación, la preparación de la biomasa celular y las condiciones gastrointestinales afectan la eficiencia de la unión de las micotoxinas por las bacterias (Lach et al., 2024).
Numerosos estudios han demostrado que diversas bacterias ácido lácticas y bacterias del género Bifidobacterium, ambos probióticos generalmente reconocidos como GRAS y/o con QPS, se comportan como inhibidores del crecimiento de hongos, previniendo la producción de micotoxinas, y también pueden desintoxicar micotoxinas a través de mecanismos como la unión física (bioadsorción a los peptidoglicanos y polisacáridos de la pared celular de la bacteria) y/o la biodegradación (Lach et al., 2024).
Entre las bacterias ácido lácticas existe un grupo central compuesto por cuatro géneros: Streptococcus, Leuconostoc, Pediococcus y Lactobacillus (Figura 1).

Figura 1. Fotografía de microscopio electrónico de barrido de un Lactobacillus acidophilus. 10.000X
Los siguientes géneros conforman el grupo restante tras cambios taxonómicos recientes que impulsaron la adición de varios nuevos: Aerococcus, Alloiococcus, Carnobacterium, Dolosigranulum, Enterococcus, Globicatella, Lactococcus, Oenococcus, Tetragenococcus, Vagococcus y Weissella.
Además, recientemente, y basándose en este enfoque polifásico, el género Lactobacillus fue reclasificado en 25 géneros, considerado el modificado, que incluye organismos adaptados al huésped que se han denominado grupo Lactobacillus delbrueckii, Paralactobacillus y 23 géneros nuevos (Zheng et al., 2020).

Bacterias % AFB1 removida
Lactobacillus acidophilus P22
Lactobacillus acidophilus Po7
Lactobacillus acidophilus Po11
Lactobacillus acidophilus Po1
Ligilactobacillus salivarius M4 (CRL 1384)
Lactobacillus acidophilus CRL 1014
42,85 ± 1,67
34,62 ± 1,56
30,68 ± 8,78
28,46 ± 9,21
26,32 ± 9,55
25,38 ± 0,70
Lactobacillus spp. Jun 6 16,78 ± 3,87
Enterococcus faecalis CA 14,31 ± 7,69
Lacticaseibacillus rhamnosus CRL 1224 13,48 ± 6,77
Limosilactobacillus fermentum subesp. celobiosus 408 13,23 ± 9,77
Lactobacillus spp. L3LBS2 12,02 ± 5,47
Limosilactobacillus fermentum 27A 11,40 ± 0,13
Ligilactobacillus animalis L3 8,76 ± 5,24
Enteroccus faecium J96 7,23 ± 6,83
Entre los puntos fuertes de la bioadsorción de las bacterias ácido lácticas y del género Bifidobacterium a las micotoxinas se destacan que el tipo de unión es independiente de la viabilidad bacteriana y que la unión es instantánea (Tabla 2). Sin embargo, la unión puede ser reversible, en especial con células viables (Bueno et al., 2007).
Además, se conoce que el mucus intestinal disminuye la adsorción de las aflatoxinas a las bacterias ácido lácticas y que la co-incubación de diversas toxinas afecta el porcentaje de toxina unida por las bacterias antes nombradas, lo que indica que estas toxinas pueden compartir el mismo sitio de unión en la superficie bacteriana.
Tabla 1. Porcentaje de aflatoxina B1 (AFB1) eliminada por diferentes bacterias viables luego de 1 hora de incubación a 37ºC. Cada valor corresponde a la media ± desvío estándar en ensayos por duplicado (Bueno et al., 2007).
A su vez, este tipo de bacterias producen varios compuestos antifúngicos como ácido láctico, peróxido de hidrógeno y otros péptidos bioactivos, que pueden inhibir el crecimiento de hongos y la producción de micotoxinas.
Por ejemplo, a partir de experimentos in vitro y un modelo de alimentación, se observó que Lactobacillus acidophilus CIP 76.13T y Lactobacillus delbrueckii subsp. bulgaricus CIP 101027T son candidatos en la industria alimentaria para disminuir la contaminación por las micotoxinas ocratoxina A, aflatoxina B1, ZEA, y DON.

Se sugiere que un mecanismo de unión es responsable de la eliminación de las dos primeras, mientras que la biodegradación puede ser responsable de las reducciones de DON y ZEA (Ragoubi et al., 2021).
Por otro lado, la bacteria Eubacterium BBSH 797, que proviene del líquido ruminal de vacas, reduce el DON, por medio de su epoxidasa al metabolito menos tóxico conocido como deepoxi-deoxinivalenol (DOM-1).
Se trató del primer microorganismo que se usó como aditivo para inactivar micotoxinas en piensos. La EFSA emitió un dictamen positivo en relación con la seguridad del producto con esta bacteria para aves y cerdos, el usuario, el ambiente y el consumidor, bajo las condiciones sugeridas (Nešic et al., 2021).

La bacteria Sphingopyxis sp. MTA 144, aislada de tierra compostada, degrada la fumonisina B1 a un metabolito no tóxico 2-ceto-HFB1, mediante la acción consecutiva de dos enzimas, una carboxilesterasa y una aminotransferasa (Nešic et al., 2021).
La carboxilesterasa FumD está codificada como parte de un grupo de genes de Sphingopyxis sp. MTA 144 y permite que la cepa bacteriana degrade la fumonisina B1 a un metabolito no tóxico FB1 hidrolizado (HFB1).
Tiempo (minutos)
0 41,51 ± 1,41a 22,90 ± 0,26a
3 40,89 ± 1,97a SD
10 44,53 ± 0,34a 15,31 ± 3,55b
15 40,36 ± 2,05a SD
30 41,17 ± 1,43a SD
60 46,44 ± 4,33a 16,64 ± 0,14b
a,b Medias con diferentes letras en la misma columna difieren significativamente (P<0,05).
SD: sin datos.
Tabla 2. Porcentaje de aflatoxina B1 (AFB1) eliminada por diferentes bacterias viables luego de 1 hora de incubación a 37ºC. Cada valor corresponde a la media ± desvío estándar en ensayos por duplicado (Bueno et al., 2007).
La bacteria genéticamente modificada Escherichia coli DSM 32731 produce una enzima hidrolasa que degrada la ZEA de forma rápida, específica e irreversible en metabolitos no tóxicos y no estrogénicos. Esta enzima desintoxica a la ZEA por hidrólisis, abriendo el anillo de lactona de la misma.
Sin embargo, dado que esta bacteria alberga un gen de resistencia a la kanamicina y persisten incertidumbres sobre la posible presencia de su ADN recombinante en el producto final, la EFSA no puede concluir sobre la seguridad del aditivo para distintas especies animales, incluidas las aves, el consumidor, el usuario y el ambiente (EFSA FEEDAP Panel et al., 2022).


En cuanto a los hongos filamentosos y su capacidad desintoxicante, se ha demostrado que las especies capaces de sintetizar micotoxinas también pueden degradarlas. Por lo tanto, la aplicación de cepas no toxigénicas de Aspergillus parasiticus y A. flavus en plantas (maíz, entre otros) ha logrado buenos resultados en la eliminación de aflatoxinas.
Esto se debe a que estos hongos suelen tener la capacidad de degradar y, probablemente, de convertir y utilizar los productos de degradación (Zhang et al., 2024). Su uso está más restringido a nivel precosecha, que no es objetivo de este manuscrito.
Las levaduras probióticas o productos con pared celular de levadura se han utilizado como método de control biológico para luchar contra las micotoxinas. Varias cepas de levadura han probado ser efectivas en convertir toxinas en productos no tóxicos o menos tóxicos. Por otro lado, ciertas cepas evitan el crecimiento de hongos filamentosos.
La utilización de levaduras en diversos tratamientos tecnológicos puede ejercer un efecto inhibitorio directo sobre la producción de toxinas por algunos hongos, mientras que ciertas especies son capaces de concentrar micotoxinas provenientes de productos agrícolas, logrando así desintoxicarlos con éxito (Nešic et al., 2021).
La ventaja de las levaduras es que solo tienen necesidades nutricionales y pueden asentarse en superficies secas durante períodos más largos, además de tolerar diversos pesticidas utilizados en las condiciones de postcosecha.
A diferencia de muchos hongos miceliales, las levaduras en su mayoría no producen esporas alergénicas ni micotoxinas, y tampoco son capaces de sintetizar metabolitos antibióticos, que sí pueden ser producidos por antagonistas bacterianos.
Además, pueden proliferar rápidamente en fermentadores empleando sustratos asequibles, por lo que son convenientes para la producción en grandes cantidades.
El uso de levaduras es inocuo para los humanos, los animales, las plantas hospedantes o el ambiente, y es improbable que los organismos objetivos generen resistencia (Nešic et al., 2021).
La efectividad de Saccharomyces cerevisiae en disminuir las toxinas fúngicas que se encuentran en forrajes y materias primas ha sido verificada por diferentes experimentos. Se ha comprobado que la combinación de las micotoxinas ocurre a los 10 minutos después de mezclarlas con el producto.
El mecanismo de eliminación de toxinas, como las bacterias ácido lácticas, también incluye la adhesión a la superficie celular. La habilidad para eliminar micotoxinas no depende de la clase de toxina.
La presencia de β-D-glucano en las paredes celulares de las células de levadura, sobre todo en su forma esterificada, es la responsable del potencial de unión a toxinas por parte de estas.

Las moléculas de β-D-glucano se unen con los grupos de lactosa, cetona e hidroxilo de las toxinas a través de las interacciones de Van der Waals y los enlaces de hidrógeno que se crean (Lach y Kotarska, 2024; Mirseyed et al., 2024). El hecho de que las células de levadura puedan formar complejos con toxinas posibilita el empleo de preparaciones de levadura como aditivos para la alimentación.
La cepa de levadura Trichosporon mycotoxinivorans MTV (MTV), aislada del intestino de una termita, desintoxica tanto la ocratoxina A como la ZEA. Dado que la MTV puede fermentarse, concentrarse, liofilizarse y estabilizarse sin perder su capacidad desactivadora, se usa como aditivo alimentario.
El MTV desintoxica la ocratoxina A mediante la ruptura de su enlace amida, lo que resulta en el aminoácido fenilalanina y la fracción ocratoxina α, que es significativamente menos tóxica que su compuesto original. A su vez, esta levadura transforma ZEA en un metabolito no estrogénico (ZOM-1).
Los agentes de control biológico tienen que ser asequibles para los que producen alimentos y piensos, y estar estructurados de tal manera que su manipulación sea segura y sencilla.
Su efectividad podría optimizarse a través de la selección de cepas microbianas más eficaces, la manipulación genética, la mezcla de un mayor número de ingredientes y la incorporación de otros bioproductos que tengan un efecto sinérgico.
Además, estudios in vitro demuestran que la pared celular del MTV se puede utilizar para unir diferencialmente cepas de E. coli y Salmonella spp., con el consiguiente uso en el control de esos patógenos.
Una cepa genéticamente modificada de Komagataella phaffi (anteriormente Komagataella pastoris) degrada la fumonisina B1 (FB1) y otras fumonisinas contaminantes relacionadas en el tracto digestivo animal. La sustancia activa, la enzima fumonisina esterasa, rompe los enlaces diéster, libera ácido tricarbalílico y está diseñada para reducir la toxicidad del alimento contaminado.
La EFSA considera a esta enzima segura para aves y cerdos, el usuario, el ambiente y el consumidor, bajo las condiciones sugeridas (EFSA FEEDAP Panel et al., 2016).
A pesar de que el biocontrol de las micotoxinas es una estrategia con un futuro alentador, es importante que se aplique junto con buenas prácticas agrícolas y una adecuada gestión postcosecha, particularmente la clasificación y el almacenamiento apropiado. Para considerar que un método de descontaminación particular o un consorcio de microorganismos es seguro y eficaz, se debe determinar la toxicidad de los productos de degradación de micotoxinas resultantes.
A su vez, se deben realizar numerosas pruebas y evaluar los resultados con el objetivo de eliminar cualquier sospecha sobre posibles efectos adversos de los microorganismos ensayados y/o sus enzimas para la salud vegetal, animal y humana, así como para el ambiente.


INTRODUCCIÓN
Las dietas para pollos de engorde dependen en gran medida del trigo, el maíz y la harina de soja, los cuales contienen factores antinutricionales como los polisacáridos no amiláceos (NSP) y ácido fítico, que limitan la utilización de nutrientes.
Para contrarrestarlos, los fabricantes de piensos utilizan ampliamente enzimas exógenas que descomponen estos compuestos. Cada enzima actúa sobre diferentes sustratos, ya que son químicamente diversos, liberando así nutrientes atrapados y reduciendo las ineficiencias digestivas.
La descomposición del ácido fítico (fitato), que es la principal forma de almacenamiento de fósforo en las semillas de las plantas, puede ser catalizada por la fitasa. Al romper el fitato, la fitasa libera fósforo en una forma que el ave puede absorber, mejorando así la digestibilidad del fósforo y reduciendo la necesidad de fosfato inorgánico suplementario.

El fitato también se une a minerales (Ca, Zn, etc.) y proteínas en el intestino; la fitasa mitiga estas interacciones antinutricionales, lo que conduce a una mejor absorción de minerales y utilización de aminoácidos. El uso de fitasa está bien establecido, y las enzimas adicionales deben demostrar su eficacia junto con la fitasa.
Los NSP presentes en los ingredientes vegetales del pienso también tienen un efecto antinutritivo, ya que los animales monogástricos carecen de enzimas endógenas para descomponerlos.
Esto dificulta la utilización eficiente de nutrientes como la energía, las proteínas o los aminoácidos. Diversos NSP están presentes en las dietas típicas de monogástricos en diferentes concentraciones y formas, tanto solubles como insolubles.
Por ejemplo, el trigo contiene principalmente NSP solubles en forma de arabinoxilanos, mientras que la cebada y la avena son ricas en β-glucanos. En la harina de copra, el manano es prevalente, y también puede encontrarse en fuentes proteicas como la harina de soja.

Las enzimas carbohidrasas más utilizadas en los piensos para aves de corral
La xilanasa actúa sobre los arabinoxilanos, una fracción importante de la fibra hemicelulósica presente en cereales (especialmente trigo, centeno y maíz). Los arabinoxilanos solubles aumentan considerablemente la viscosidad intestinal en las aves, lo que perjudica la digestibilidad y el funcionamiento del tracto digestivo.
La xilanasa rompe la estructura de los arabinoxilanos en xilooligosacáridos (XOS) más pequeños, reduciendo la viscosidad del contenido intestinal y “liberando” nutrientes atrapados que estaban físicamente encerrados por la fibra de la pared celular. Los productos de descomposición (XOS) también pueden actuar como sustratos prebióticos que favorecen la salud intestinal.
La β-glucanasa hidroliza los β-glucanos, otro tipo de fibra NSP presente notablemente en cereales como la cebada, la avena y, en menor medida, el trigo. Al igual que los arabinoxilanos, los β-glucanos solubles aumentan la viscosidad intestinal y reducen la absorción de nutrientes.


La β-mananasa descompone los β-mananos como e l galactomanano, que se encuentra en la harina de soja, la harina de palmiste y otras legumbres. La mananasa rompe los β-mananos en manno-oligosacáridos (MOS) más cortos, reduciendo la viscosidad del contenido intestinal y disminuyendo el efecto antinutricional. Los MOS liberados pueden además tener efectos prebióticos, como ya se explicó para los XOS.
La especificidad del sustrato subraya la lógica de combinar enzimas exógenas
NSP para actuar eficazmente sobre estos diversos compuestos.
Los efectos nutricionales de los NSP en animales monogástricos son variados y, en algunos casos, significativos. Se reconoce ampliamente que las principales desventajas de los NSP están relacionadas con la naturaleza viscosa de estos polisacáridos, sus efectos fisiológicos y morfológicos sobre el tracto digestivo, y su interacción con la flora intestinal.
¿Qué beneficio podríamos esperar si usamos diferentes enzimas a la vez?
1 +1 +1 = >3
1 +1 +1 = 3
1 +1 +1 = <3
Enzima A sola
Enzima B sola
Enzima C sola Subaditividad
Esto es precisamente lo que se investigó en un estudio realizado en la Universidad de Nueva Inglaterra (Kim et al., 2025) mediante un ensayo de alimentación. El diseño experimental se muestra en la figura 1.

Aditividad Sinergismo
Tratamiento P PXG


Figura 1. Diseño experimental, tratamientos, composición de la dieta y régimen de alimentación.
Todas las dietas experimentales contenían fitasa (Natuphos® E, 1000 FTU/kg de pienso). Además, se incluyó uno de los siguientes suplementos enzimáticos junto con la fitasa: una mezcla de xilanasa–glucanasa proporcionada por Natugrain® TS (PXG), una β-mananasa proporcionada por Natupulse® TS (PM), o la combinación de xilanasa, glucanasa y β-mananasa (PXGM).
384 Cobb 500 pollitos broiler de ambos sexos 8 corrales con 12 aves por tratamiento
Dieta de 3 fases (d0-10 / d10-21 / d21-35)
Composición de la dieta (%)
Trigo (56 / 58 / 60)
Harina de soja (32 / 29 / 25)
Salvado de trigo (5 / 7,5 / 10)
Valores calculados
AME, kcal/kg (3084 / 3080 / 3094)
AME, MJ/kg (12,9 / 12,9 / 13,0)
Proteína bruta, % (23,8 / 22,6 / 21,4)
Entre los días 17 y 20 del ensayo, se recolectaron excretas. Los efectos de las carbohidrasas sobre la desaparición de los NSP solubles se muestran en la Figura 2.
Figura 2. Retención de NSP soluble (%)

Se observa claramente un efecto sinérgico de las enzimas NSP sobre la tasa de desaparición de los NSP solubles. La adición de la combinación xilanasa–glucanasa resultó en una retención de NSP un 19,4% mayor, y la suplementación con β-mananasa sola produjo una retención un 8,5% mayor.
La combinación de las tres enzimas
NSP (xilanasa, glucanasa y β -mananasa) generó un aumento del 39,1% en la retención de NSP en comparación con la dieta sin enzimas NSP.
Cuando las moléculas de fibra específicas del sustrato son degradadas por las carbohidrasas adecuadas, se producen oligosacáridos como los xilooligosacáridos (XOS) y los manano-oligosacáridos (MOS), que pueden modular el microbioma.
Este efecto prebiótico puede reflejarse en un aumento de la concentración total de ácidos grasos de cadena corta (AGCC), entre ellos el butirato, como se muestra en la Figura 3.
Cada una de las enzimas NSP individuales aumentó nominalmente la producción total de AGCC en comparación con el control, observándose el mayor efecto en el tratamiento combinado (PXGM) (p = 0,051). En comparación con el control, la combinación de las tres carbohidrasas produjo un aumento significativo en la concentración de butirato en el ciego.
El butirato, en particular, es conocido por su efecto en la mejora de la función de la barrera intestinal, por servir como fuente de energía para el huésped y por su capacidad para modular la respuesta inmunitaria.
En conjunto, estos efectos pueden contribuir a una mejor absorción de nutrientes y metabolismo, lo cual puede reflejarse en un mejor rendimiento animal, como se observó en este estudio.

P=0,051
AGCC total, µmol/g
Natuphos® E Natuphos® E Natuphos® E
P<0,05
Natuphos® E Natuphos® E Natuphos® E
Natugrain® TS Natugrain® TS
Natugrain® TS Natugrain® TS
total, µmol/g Butirato en el ciego, μmol/g
Natuphos® E
Natuphos® E
Natugrain® TS Natugrain® TS Natupulse® TS
Natugrain® TS Natugrain® TS Natupulse® TS
Butirato en el ciego, μmol/g
Natupulse® TS
Natupulse® TS

Figura 3. Influencia de las carbohidrasas en la producción total de ACCG y butirato.
Natuphos® E Natuphos® E Natuphos® E
Natuphos® E Natuphos® E Natuphos® E
Natugrain® TS Natugrain® TS
Natugrain® TS Natugrain® TS
Natuphos® E
Natuphos® E

Natugrain® TS Natugrain® TS Natupulse® TS Natupulse® TS
Natugrain® TS Natugrain® TS Natupulse® TS Natupulse® TS
También se determinó la digestibilidad de la energía a partir de las excretas recolectadas. La combinación de todas las enzimas (PXGM) tendió a mejorar la Energía Metabolizable Aparente (AME) en 44 kcal o 0,15 MJ ME en comparación con el grupo que solo recibió fitasa (P) (Figura 4), y el peso corporal también tendió a ser mayor en el día 35 (Figura 5).
El uso de enzimas NSP redujo significativamente el índice de conversión alimenticia durante todo el período experimental de 35 días, sin observarse diferencias entre los grupos tratados con enzimas NSP (Figura 5).

Figura 4. Las aves pueden aprovechar más energía del alimento suplementado con la combinación de enzimas.
Natuphos® E Natuphos® E Natuphos® E
Natugrain® TS Natugrain® TS
Natuphos® E
Natugrain® TS Natugrain® TS Natupulse® TS Natupulse® TS
Natuphos® E Natuphos® E Natuphos® E
Natugrain® TS Natugrain® TS
Figura 5. Peso al día 35 e IC total. El uso de carbohidrasas tiene un efecto positivo en el rendimiento.
Natuphos® E
Natugrain® TS Natugrain® TS Natupulse® TS Natupulse® TS
Diferentes enzimas actúan sobre diferentes sustratos. Al degradar estos sustratos, liberan nutrientes, y sus mecanismos de acción pueden interactuar positivamente, produciendo en algunos casos efectos sinérgicos.
Esto amplía el espectro funcional de la suplementación enzimática, ayudando a amortiguar la variabilidad natural en la composición de las materias primas y permitiendo el uso de ingredientes que, de otro modo, estarían limitados en las dietas debido a sus factores antinutricionales.
Esta flexibilidad en la formulación impulsada por enzimas puede reducir los costes del alimento y mejorar la eficiencia nutricional en pollos de engorde. Además, al facilitar el uso de subproductos o materias secundarias, apoya enfoques de economía circular que mejoran la sostenibilidad global.
Bibliografía disponible bajo solicitud.
combinado de enzimas en la nutrición de pollos de engorde: mecanismos,
A medida que crece la demanda de animales criados de manera más sostenible, también lo hace el rendimiento de nuestros ingredientes eficientes de máxima calidad.
Vitaminas
Carotenoides
Enzimas
Ácidos orgánicos
Glicinatos
Monoglicéridos
The science of sustainable feed that succeeds


INTRODUCCIÓN
Sol C1, Villalobos G1, Horta F1, López R1,2, Lee J3 y Kim W K3
1 Nuproxa Suiza, Vaud, Suiza.
2Nuproxa Mexico, Querétaro, México.
3 Departamento de Ciencias Avícolas, Universidad de Georgia, Athens, GA, EUA.
MATERIAL Y MÉTODOS
Las crecientes preocupaciones sobre el uso de medicamentos, aditivos sintéticos y la resistencia microbiana en la producción avícola han aumentado el interés en los suplementos fitogénicos.
Este estudio se llevó a cabo para investigar los efectos de la suplementación con un producto poliherbal a base de Acacia concinna, entre otras plantas (NuxaSan™, Nuproxa, Suiza) sobre el desempeño, índice de lesiones intestinales y de infección en pollos de engorde desafiados con Eimeria spp.
Un total de 288 pollos de engorde Cobb 500 machos de un día de edad se distribuyeron aleatoriamente en 3 tratamientos con 8 repeticiones por tratamiento y 12 aves por jaula durante 28 días.
Los tratamientos fueron: Control negativo, NC (dieta basal, sin desafío), Control Positivo, PC (dieta basal, animales desafiados con Eimeria spp.) y NuxaSan, NS (dieta suplementada con 500ppm de NuxaSan, animales desafiados con Eimeria spp.). Las aves de los grupos PC y NS fueron inoculadas de forma oral con 62.500 ooquistes de E. acervulina, 12.500 ooquistes de E. maxima y 12.500 ooquistes de E. tenella el día 14, y el grupo NC fue inoculado oralmente con la misma cantidad de PBS.
Los datos se analizaron estadísticamente utilizando JMP 16.0 (SAS Institute Inc, Cary, NC). Las medias de tratamiento se separaron mediante la prueba de Tukey HSD. Las puntuaciones de las lesiones se analizaron mediante la prueba de Chi-cuadrado de Pearson para identificar diferencias significativas entre los tratamientos. La significación estadística se consideró a P<0,05, con mayor significancia se indicó a P<0,001.
RESULTADOS
CONCLUSIONES
Los resultados de desempeño mostraron que a los 28d, las aves del grupo NS fueron las más pesadas (1.648a, 1.495b y 1.704a, expresadas en gramos, para NC, PC y NS, respectivamente, P=0,0002), con menor conversión alimenticia (1,40b, 1,45a y 1,39b, para NC, PC y NS, respectivamente, P=0,0014) y la mortalidad más baja (1,04%, 2,08% y 0,00%, respectivamente).
El grupo NS logró una reducción significativa de la excreción de ooquistes (P<0,05) de E. tenella a los 6-7-8-9 días después de la inoculación (DPI), E. maxima a 7 y 9 DPI y E. acervulina a 6 DPI (P=0,055).
Además, la suplementación con NuxaSan disminuyó (P<0,0001) la puntuación de incidencia de lesiones graves en duodeno (0,00c, 2,63a, 2,00b) y ciego (0,00c, 2,13a y 1,38b) para NC, PC y NS.
Para la expresión génica, el desafío de Eimeria spp. aumentó (P<0,05) la expresión de claudina 1 (CLDN-1) y citocinas proinflamatorias: interleucinas IL-1β, IL-6, TNF-α e IFN-γ en yeyuno en el grupo NC; en contraste, para el grupo NS la expresión génica de CLDN-1 e IL-1β, TNF-α en yeyuno se redujo (P<0,0001) pero aumentó numéricamente la enzima glutation peroxidasa (GPX) en yeyuno en comparación con PC.
La suplementación con 500 ppm de NuxaSan mitigó los efectos negativos causados por el desafío con Eimeria spp.
IMPLICACIONES
NuxaSan es una herramienta alimentaria a ser considerada para composición de dietas de pollos sometidos a desafío por Eimeria spp. en campo.
Efecto de la suplementación con NuxaSan sobre el desempeño y la salud intestinal en pollos desafiados con Eimeria spp. DESCÁRGALO EN PDF
Braulio de la Calle Campos
DT Rumiantes Coren Agroindustrial SAU y responsable Departamento Vacuno de Carne en Coren Sociedad Cooperativa



En los animales, aproximadamente el 80 % del fósforo presente en el organismo se encuentra en los huesos y dientes que, además de brindar soporte estructural, actúan como una reserva de este mineral.

En el caso de los rumiantes, el fósforo es, además, necesario para el funcionamiento del microbiota del rumen, donde la importancia de este elemento es doble.

La presencia de fitasas y fosfatasas microbianas en el rumen les permite aprovechar gran parte del fósforo fítico presente en los vegetales.
En este sentido, la actividad de la
El 20 % restante está distribuido en otros componentes, donde desempeña funciones esenciales en procesos biológicos como:
La transferencia de energía.
El transporte de ácidos grasos volátiles (AGV).
La síntesis de proteínas.
El equilibrio ácido-base.
La división y multiplicación celular.
El metabolismo del nitrógeno en vacuno lechero está estrechamente relacionado con el aporte de fósforo, ya que una ingesta insuficiente de este mineral afecta a la fermentación ruminal, lo que se traduce en una menor síntesis de proteína microbiana y una reducción en la digestibilidad de los

absorción del fósforo ocurre principalmente intestino delgado, pudiendo ser:
Retenido para funciones productivas.
Secretado en el lumen intestinal, donde puede ser reabsorbido o eliminado en las
La homeostasis del fósforo se regula principalmente a través del reciclaje en la saliva y la excreción fecal endógena.
Por ello, la estimación de su digestibilidad basada únicamente en la diferencia entre la ingesta y la excreción carece de valor en la evaluación de este nutriente.
Tracto gastrointestinal
Ingestión de P Excreción de P
Orina Tejidos Blandos
Figura 1. Diagrama del metabolismo del fósforo en rumiantes. El fósforo ingerido pasa al rumen y al tracto gastrointestinal, donde parte es absorbido y distribuido a través del plasma hacia los huesos y tejidos blandos. También se recicla a través de la saliva y se elimina principalmente por la orina y las heces, regulando así su homeostasis en el organismo.
Dada su importancia en el mantenimiento de las funciones biológicas, una deficiencia en los aportes de fósforo puede conllevar serios efectos negativos.
Los primeros signos de deficiencia de fósforo suelen ser inespecíficos y, por ello, no siempre se identifican de inmediato.
Entre ellos, se encuentran la reducción del consumo y la eficiencia en la utilización del alimento, lo que conlleva una merma en el ritmo de crecimiento.
También pueden observarse fenómenos de pica* o alteraciones del comportamiento.
*Trastorno del comportamiento en el que los animales ingieren sustancias no nutritivas o inusuales, como tierra, madera, huesos o plásticos. En rumiantes, suele estar asociado a deficiencias nutricionales, como la falta de fósforo, sodio o fibra efectiva, y puede afectar su salud y rendimiento productivo.
Si la deficiencia persiste, los animales presentarán anorexia y pérdida de peso. Además, según su estado productivo, pueden presentarse problemas como:
Disminución de la fertilidad.
Retrasos en la concepción.
Menor producción de leche.

Para prevenir su déficit, el fósforo se incorpora de manera rutinaria en piensos y raciones a través de fuentes minerales, principalmente fosfatos de origen mineral, como meta, piro u ortofosfatos.
Además, este macromineral puede estar presente en los alimentos de origen vegetal, animal o mineral, lo que influye en su disponibilidad y aprovechamiento por parte del animal.
Oligoelemento Bis-Quelado
Un producto NOVUS
novusint.com/dairyminerals


SOLO MINTREX® OLIGOELEMENTO BIS-QUELADO OFRECE LA ABSORCIÓN
PROACTIVA QUE NECESITAS PARA MAXIMIZAR LA NUTRICIÓN.
Nuestros auténticos oligoelementos orgánicos son los únicos minerales comprobados que sobreviven al tracto digestivo y alcanzan el sitio de absorción, proporcionando un mayor enriquecimiento tisular. Así, tus vacas tienen todo lo que necesitan para mantener la productividad, incluso frente a desafíos inesperados. MINTREX® Oligoelemento Bis-Quelado ayuda a tus vacas a desarrollar resiliencia estructural desde adentro hacia afuera – promoviendo mayor movilidad, cascos más fuertes y longevidad tanto operativa como del rebaño durante muchos años.
® y MINTREX son marcas registrada de Novus International, Inc. en los Estados Unidos y en otros países. ©2025 Novus International, Inc. Todos los derechos reservados.
Exceso de fósforo

Bloqueo de la radiación solar
Sobrecrecimiento materia vegetal
Deficiencia de oxígeno

Proliferación de microorganismos descomponedores de materia orgánica
Figura 2. Proceso de eutrofización en ecosistemas acuáticos debido al exceso de fósforo. El aporte excesivo de este nutriente provoca un crecimiento descontrolado de la materia vegetal, lo que bloquea la radiación solar y reduce la fotosíntesis. Como consecuencia, disminuye la concentración de oxígeno en el agua, favoreciendo la proliferación de microorganismos descomponedores y generando una pérdida de biodiversidad en el ecosistema.
En la actualidad, el fósforo se considera un factor clave en los procesos de eutrofización de suelos y ecosistemas acuáticos.
Un aumento en su concentración en estos entornos favorece el crecimiento excesivo de materia vegetal, lo que dificulta la transmisión de la radiación solar, reduciendo la fotosíntesis y el nivel de oxígeno en el agua.
Paralelamente, aumenta la actividad de los microorganismos descomponedores de materia orgánica y, con ello, el consumo de oxígeno.
Estos cambios alteran las condiciones del ecosistema, disminuyendo la diversidad biológica y afectando la fauna acuática.
Desde un punto de vista ambiental, es fundamental ajustar el contenido de fósforo en las raciones para evitar un aporte excesivo, ya que los animales lo eliminan al medio, generando un impacto significativo en los ecosistemas.
¡No todo el fósforo ingerido es absorbido!
En el caso de forrajes verdes de praderas permanentes o cereales, la absorción alcanza aproximadamente el 70 %, mientras que en los cereales en grano llega al 75 %.
El fósforo absorbido que no es retenido en los tejidos o productos es eliminado a través de la orina o reciclado al tracto digestivo mediante la saliva, para ser finalmente reabsorbido o expulsado en las heces.
La cantidad de fósforo eliminado a través de la orina aumenta conforme aumenta el aporte del mineral, pero representa una proporción muy pequeña respecto al fósforo eliminado en las heces, donde se elimina fósforo de diferentes procedencias, lo que da lugar a diferentes fracciones:
El fósforo aportado por el alimento que no ha sido absorbido.
El fósforo asociado a las secreciones digestivas y a las células del tracto digestivo que se desprenden de la pared.
El fósforo asociado a la población microbiana que se elimina en las heces.
El fósforo reciclado con la saliva y que no ha sido reabsorbido o utilizado por la población microbiana.
La excreción de fósforo al medio aumenta a medida que se incrementa su ingesta. Sin embargo, este aumento proviene principalmente del fósforo ingerido que no ha sido absorbido, ya que la excreción endógena, conocida como "pérdidas inevitables", se mantiene relativamente constante.
Hasta hace relativamente poco, la formulación de dietas se ha basado en amplios márgenes de seguridad, lo que, en muchos casos, ha resultado en un aporte excesivo de fósforo.

As a feed additive specialist, we bring the latest nutritional science into our solutions, ensuring progress and viability in animal farming.


Mantener unos niveles óptimos de fósforo en la dieta es fundamental, ya que favorece la fertilidad, el consumo de alimento, la producción de leche y la salud ósea. Además, en animales en crecimiento, una ingesta adecuada de este mineral previene la deformación del esqueleto y garantiza una eficiencia alimentaria óptima.
Para preservar la salud de los animales y optimizar tanto la producción lechera como el crecimiento, es esencial ajustar correctamente los niveles de fósforo en la dieta.
Actualmente, gracias a los sistemas modernos de racionamiento y al uso de criterios de nutrición de precisión, resulta más sencillo afinar la formulación mineral y evitar excesos innecesarios.
Las recomendaciones sobre el aporte de fosfato varían considerablemente. Sin embargo, se considera que una ración con un promedio de 3,5 g de fósforo/kg de materia seca es suficiente para una vaca lactante con una producción de 10.000 kg de leche.
A modo de referencia, pueden seguirse las siguientes pautas nutricionales:
Terneros pequeños: 3,4 g/kg MS
Terneros mayores y novillas: 2,3 g/kg MS
Vacas secas: 2,0 g/kg MS
Vacas lecheras:
Producción de 20 kg de leche: 2,5 g/kg MS
Producción de 40 kg de leche: 3,3 g/kg MS
Producción de más de 40 kg de leche: 3,5 g/kg MS
La mayoría de las dietas se sitúan dentro de un rango de 0,32-0,38 g de fósforo por cada 100 g de materia seca, en línea con las recomendaciones actuales del NRC para vacas de raza Holstein, dependiendo principalmente del nivel de producción de leche.
Sin embargo, un porcentaje significativo de las raciones supera los 0,38 g/100 g MS, lo que puede resultar en excreciones de fósforo superiores a 60 g/día por animal.
Este exceso no solo representa un desperdicio económico, sino que también tiene un impacto ambiental considerable, especialmente si los purines o el estiércol no se gestionan adecuadamente, contribuyendo a la contaminación del suelo y del agua.
La reducción del fósforo en la dieta de las vacas lecheras debe realizarse sin comprometer su rendimiento productivo, siendo fundamental asegurar un aporte adecuado que permita el funcionamiento óptimo del rumen, especialmente en la digestión de la celulosa.
Una ingesta insuficiente de fósforo puede afectar la tasa de fermentación ruminal, disminuyendo la digestibilidad de los nutrientes y reduciendo la eficiencia en la producción de proteína microbiana.
Como consecuencia, tanto el metabolismo como la utilización del nitrógeno pueden verse afectados por un nivel inadecuado de fósforo en la dieta.
PRINCIPALES CAMBIOS INTRODUCIDOS POR LA NORMATIVA:
En los últimos años, numerosos estudios han analizado los requerimientos de nitrógeno y fósforo en el vacuno lechero con el objetivo de minimizar su excreción. Sin embargo, la mayoría de estas investigaciones han evaluado un nutriente de forma aislada, manteniendo fija la concentración del otro.
Para abordar esta limitación, un grupo de investigadores de China llevó a cabo un estudio en el que se analizó el efecto de la variación simultánea de los niveles de proteína y fósforo en la dieta.
Los resultados revelaron que reducir la proteína bruta del 17 % al 15 % y el fósforo del 0,44 % al 0,34-0,39 % no afecta el consumo de alimento, la digestibilidad, la fermentación ruminal, la producción lechera ni los metabolitos plasmáticos.
Esto sugiere que es viable reducir los niveles de proteína y fósforo en la dieta como estrategia para disminuir la excreción de estos nutrientes sin comprometer el rendimiento animal.
NORMATIVA SOBRE LA GESTIÓN DEL FÓSFORO
El Real Decreto 1051/2022, de 27 de diciembre, por el que se establecen normas para la nutrición sostenible en los suelos agrarios consolida los cambios anunciados en la gestión de purines y fertilizantes, regulando cómo, cuándo y cuánto fósforo puede aplicarse en los terrenos agrícolas.
El objetivo principal de esta norma es reducir las emisiones de gases, especialmente amoníaco, y prevenir la contaminación del agua y el suelo.
LEER RD 47/2022
Si el titular de la explotación realiza la valoración agronómica de los estiércoles en el suelo, deberá contar con superficie agrícola suficiente, ya sea propia o concertada.
La cantidad de estiércoles aplicados deberá ajustarse a lo dispuesto en el Real Decreto 47/2022, de 18 de enero, calculando el contenido de nitrógeno del estiércol con base en las tablas zootécnicas para el balance de nitrógeno y fósforo.
Cálculo obligatorio de las necesidades de nitrógeno y fósforo, con la recomendación de incluir también el potasio.
Obligatoriedad de un plan de abonado para todas las explotaciones.
Durante cinco años consecutivos, no se podrá superar los aportes efectivos calculados en más de un 10 % para el nitrógeno y en más de un 20 % para el fósforo y el potasio.
Con 2,5 UGM de vacuno por hectárea, no sería necesario adquirir fertilizantes adicionales de fósforo y potasio.
En los últimos años, la regulación ambiental en la Unión Europea ha impulsado medidas más estrictas para reducir el impacto de la ganadería en el medio ambiente.
En este contexto, Holanda ha implementado un plan de reducción de fosfatos con el objetivo de disminuir las emisiones derivadas de la producción lechera. Sin embargo, esta estrategia conlleva importantes consecuencias para el sector, afectando tanto el censo ganadero como la producción de leche.
El Plan de reducción de fosfatos prevé una disminución de la producción de leche entre un 6 % y un 10 %, así como una reducción del censo de vacas en un 6 %.
El Gobierno de La Haya ha diseñado cinco áreas de trabajo con las que espera reducir las emisiones de fosfatos en 10,8 millones de kg, superando en 4,2 millones de kg la cantidad inicialmente requerida.

Así, dependiendo de las medidas que adopten los productores para cumplir con los objetivos, la producción de leche holandesa podría disminuir entre un 6% y un 10%.
Cierre de explotaciones (2,5 millones de kg de fosfatos)
Para fomentar la reducción del censo ganadero, se implementarán tres rondas de licitación en las que el incentivo económico disminuirá progresivamente para incentivar una adopción temprana de la medida.
Se ofrecerá una prima de 1.200 € por vaca sacrificada, además de un pago adelantado vinculado al derecho de fosfato.
El coste total del plan se estima en 50 millones de euros.
Se prevé que esta medida conlleve el sacrificio de aproximadamente 100.000 vacas.
Fósforo en la nutrición de rumiantes: eficiencia productiva y marco regulador DESCÁRGALO EN PDF
Para alcanzar los objetivos de reducción de fosfatos propuestos, el plan se estructura en varias medidas clave, cada una con un impacto directo en la producción ganadera y el censo de vacas lecheras.
Reducción de fosfatos en el sector lácteo (4 millones de kg de fosfatos) 1
Los productores de leche estarán obligados a reducir su producción o el tamaño de sus rebaños con base en un período de referencia de 2015.
Todas las explotaciones deberán pagar una tasa que aumentará si no cumplen con los requisitos establecidos.
Aquellas explotaciones que reduzcan su censo por debajo del límite podrán recibir un incentivo económico, financiado con los ingresos generados por esta tasa.
Se estima que alrededor de 60.000 vacas serán sacrificadas como resultado de esta medida, aunque algunas podrían ser exportadas a otros países de la UE o a terceros mercados.
3
Ajustes en la alimentación (1,7 millones de kg de fosfatos)
Se establecerán restricciones en la formulación de los piensos para reducir la cantidad de fósforo ingerido por los animales:
El contenido medio de fósforo en la ración deberá limitarse a 4,3 g/kg de pienso.
Se establecerá una relación fósforo/proteína del 2,2 % con el fin de optimizar la eficiencia nutricional y reducir la excreción de fosfatos al medio ambiente.
La gestión eficiente del fósforo en la alimentación animal es clave para lograr un equilibrio entre productividad y sostenibilidad
En este contexto, se cabe destacar los siguientes puntos clave:
Optimizar la formulación de las raciones mediante una alimentación de precisión permite reducir significativamente la excreción de fósforo en el estiércol, minimizando su impacto ambiental sin afectar la producción.
Ajustar los niveles de fósforo en la dieta para evitar excesos innecesarios, manteniendo el rendimiento productivo de los animales y optimizando los costes de producción.
Evaluar correctamente los niveles de fósforo en los forrajes para ajustar su inclusión en la dieta y evitar sobrealimentación con fuentes minerales.
Considerar el plan de abonado de las explotaciones, asegurando una gestión eficiente de los purines y estiércoles para optimizar el uso del fósforo en los suelos.
Implementar un plan de reducción del aporte de fósforo, garantizando siempre que las necesidades nutricionales de los animales estén cubiertas.
En definitiva, el desafío actual no solo radica en cubrir los requerimientos del ganado, sino en hacerlo de manera eficiente y responsable, alineando la producción animal con los criterios de sostenibilidad y rentabilidad.

En AuxiTech Feed Additives desarrollamos aditivos tecnológicos con el fin de optimizar el rendimiento en el proceso de fabricación de pellet de pienso y aumentar la bioseguridad.

Aditivo diseñado para mejorar el acondicionamiento y la humedad final del pienso con el fin de obtener un pellet seguro y de calidad, y a la vez reducir el consumo de energía durante el proceso de pelletización.
Potente bactericida de amplio espectro diseñado para uso en materias primas y en piensos.
Aditivo para el control fúngico en materias primas y piensos durante el almacenamiento.
completa
Guillaume Desrousseaux
Ruminant market manager, Laboratoires Phodé
Para ser más sostenibles y ahorrar en costes de alimentación, podemos reducir ligeramente la ingesta de proteínas en la ración de las vacas.
Se ha confirmado que un suplemento a base de extractos vegetales es una herramienta excelente para reducir la suplementación proteica en la dieta y mejorar los parámetros de producción.


Con aproximadamente 12 millones de granjas lecheras en toda Europa y un valor de producción que supera los 45.000 millones de euros anuales, el sector desempeña un papel fundamental en las economías rurales, la seguridad alimentaria y las tradiciones culturales.
Sin embargo, a medida que se intensifican las preocupaciones medioambientales a nivel mundial, la industria láctea se enfrenta a una presión cada vez mayor para conciliar la productividad con la sostenibilidad.


La UE ha implementado varios instrumentos políticos para impulsar la sostenibilidad:
La estrategia “De la granja a la mesa” en el marco del Pacto Verde Europeo
La Política Agrícola Común (PAC) con sus nuevos “programas ecológicos”
Iniciativas de agricultura baja en carbono que recompensan la reducción de emisiones y la captura de carbono
La Directiva sobre nitratos y otras normativas sobre la calidad del agua.
Las partes interesadas del sector lácteo europeo han respondido a estos retos con diversos enfoques para mejorar la sostenibilidad. Entre ellos, se pueden establecer técnicas de alimentación de precisión que reducen los residuos y las emisiones.
Es bien sabido que reducir la proteína en la dieta ofrece una serie de beneficios medioambientales. Menos proteína significa:

La UE importa aproximadamente entre 30 y 35 millones de toneladas de soja y harina de soja al año, gran parte de las cuales se destinan a la alimentación animal, incluida la ganadería lechera.
El coste medioambiental de la harina de soja en la alimentación de las vacas es significativo.
El cultivo de la soja es uno de los principales factores de la deforestación, especialmente en Sudamérica (Brasil, Argentina, Paraguay).
La conversión de bosques o pastizales en monocultivos de soja reduce la biodiversidad y elimina los sumideros de carbono. Si se incluyen las emisiones derivadas del cambio en el uso del suelo, la harina de soja puede tener una huella de carbono de entre 5 y 8 kg de CO₂ equivalente por kg.
Además, la demanda de soja cultivada en tierras agrícolas existentes o procedente de fuentes sostenibles certificadas supera la oferta.
Por lo tanto, se necesitan enfoques alternativos para reducir el impacto medioambiental de la producción lechera.
Aumenta de forma natural la producción de proteína de los
Esto se puede lograr de forma natural utilizando una mezcla de aceites esenciales (AE) y especias, que modulan la actividad de la microbiota ruminal y mejoran la utilización y síntesis de proteína (alimentaria).
Los ensayos demostraron que los aceites esenciales (AE, Phodé) pueden:
Aumentar la síntesis de proteína bacteriana (g N/kg OM) en un 25 % (Tabla 1).
Por lo tanto, el flujo de proteína microbiana duodenal (N) (g/día) en un 19 % (Tabla 1).
Síntesis de proteína bacteriana (g N/kg MO1) 13,5 16,9* 25%

La proteína microbiana del rumen representa entre el 50 % y el 75 % del aporte proteico total de la vaca, y se considera la proteína de mayor calidad disponible para el animal debido a su perfil de aminoácidos.
Por lo tanto, optimizar el entorno del rumen para que los microorganismos prosperen es la forma más económica y eficaz de impulsar la síntesis de proteína microbiana y aumentar la cantidad de proteína metabolizable disponible en el intestino delgado.
Un ensayo realizado en USA analizó la eficacia del AE en dietas bajas en proteína (baja inclusión de harina de soja para reducir la excreción de nitrógeno en la orina y el estiércol).
El suplemento de AE se mezcló con un tercio de la ración baja en proteína y se añadió por encima (2 gramos por vaca al día) y se comparó con una dieta de control con un nivel más alto de proteína bruta (mayor inclusión de harina de soja).
Los resultados sobre la excreción de N y la eficiencia alimentaria favorecen a la dieta baja en proteína + AE
Elemento medioambiental* Unidades

Esto se puede lograr de forma natural utilizando una mezcla de aceites esenciales (AE) y especias, que modulan la actividad de la microbiota ruminal y mejoran la utilización y síntesis de proteína (alimentaria).
Eutrofización, agua dulce
Más recientemente, se han tenido en cuenta los ingredientes de la dieta y su proporción para estimar los efectos de esta estrategia nutricional sobre el medio ambiente gracias a los análisis de ciclo de vida (ACV) según el método PEF CR Feed (Tabla 2).
El ACV reveló una huella de carbono un 7,9 % menor en la dieta con una baja inclusión de harina de soja. Esto representa un ahorro de 54,4 t de CO2- eq al año para una granja de 100 vacas, lo que equivale a más de 30 vuelos de ida y vuelta entre París y Nueva York.
Uso de recursos, fósiles
Uso del agua m3 depriv. 8,80E+02 3.15E+03 -0,86%
*Según análisis de ciclo de vida (ACV) de fórmulas dietéticas calculadas por un consultor independiente. **por tonelada de materia seca en la ración mixta total
Tabla 2. La dieta AE + baja en proteína puede ser una estrategia nutricional interesante para hacer frente a los retos medioambientales, especialmente al cambio climático.
En muchas granjas, existe la posibilidad de reducir la proteína bruta de la dieta con un riesgo mínimo de disminuir la producción de leche gracias a la inclusión de un suplemento de aceites esenciales.
Con un rumen sano y una producción microbiana activa de proteína, se puede reducir la proteína de la dieta en 1 punto.
Una mano amiga para la ganadería lechera sostenible
DESCÁRGALO EN PDF

Esta no solo es una opción atractiva desde el punto de vista financiero, sino que también reduce los problemas medioambientales asociados.
Como se ha demostrado en diferentes ensayos, añadir unos pocos gramos de una potente mezcla de aceites esenciales y especias a la dieta de las vacas puede lograrlo de forma eficaz.
¡Unos pocos gramos pueden marcar la diferencia!




Según un informe reciente de la Red de Información Agrícola Mundial (GAIN) del Servicio de Agricultura Exterior del USDA, las condiciones climatológicas extremadamente cálidas y secas en verano tuvieron un impacto negativo en la cosecha de maíz de Bulgaria de la campaña 2025/26.
De esta forma, se revisaron a la baja las estimaciones en cuanto a producción, estimadas actualmente en 1,5 Mt (1,63 Mt en el ciclo anterior), cifra que supone el volumen más bajo desde el año 2009.
Así, con la contracción de la cosecha y unos stocks iniciales menores a los previstos inicialmente, se prevé un incremento en los precios.
En este contexto, la producción de maíz se destinaría principalmente a la alimentación humana, con su procesamiento para la elaboración de almidón. A su vez, se estima que la industria avícola y porcina aumenten su demanda del cereal para la fabricación de piensos.
En consecuencia, se proyecta un ascenso de la compra de maíz en el extranjero, alcanzando un volumen de 500.000 toneladas para la temporada 2025/26.


ha experimentado un cambio gradual pero estratégico en la producción de trigo y otros cereales, migrando hacia una mayor producción de semillas oleaginosas, especialmente girasol, según datos del USDA.
Este cambio es el resultado de cuestiones económicas, climáticas, y gubernamentales.
Los beneficios de los cereales se redujeron en los últimos años. Además, los rendimientos favorables y los márgenes de beneficio decentes, motivaron a los agricultores a sembrar más oleaginosas (El rendimiento promedio del girasol pasó de 0,8 t/ha en 2014 a 1,5 t/ha en 2024).
Mientras tanto, la producción de cereales en ciertas zonas del país de menor aptitud agrícola se volvió menos viable debido al estrés climático y la degradación del suelo.
Según las estadísticas oficiales de Kazajistán, entre 2020 y 2024, la superficie cultivada con semillas oleaginosas ascendió de 2,8 Mha a más de 3,3 Mha, con el girasol como principal cultivo.
Así, en el marco de la estrategia para incentivar una mayor producción de semillas oleaginosas, el gobierno está dando a los agricultores una subvención de 48 dólares por tonelada de girasol.
Esta medida se financia mediante un impuesto de exportación del 20% aplicado al mismo producto.

Materias primas DESCÁRGALO EN PDF
22 & 23 de abril 2026











